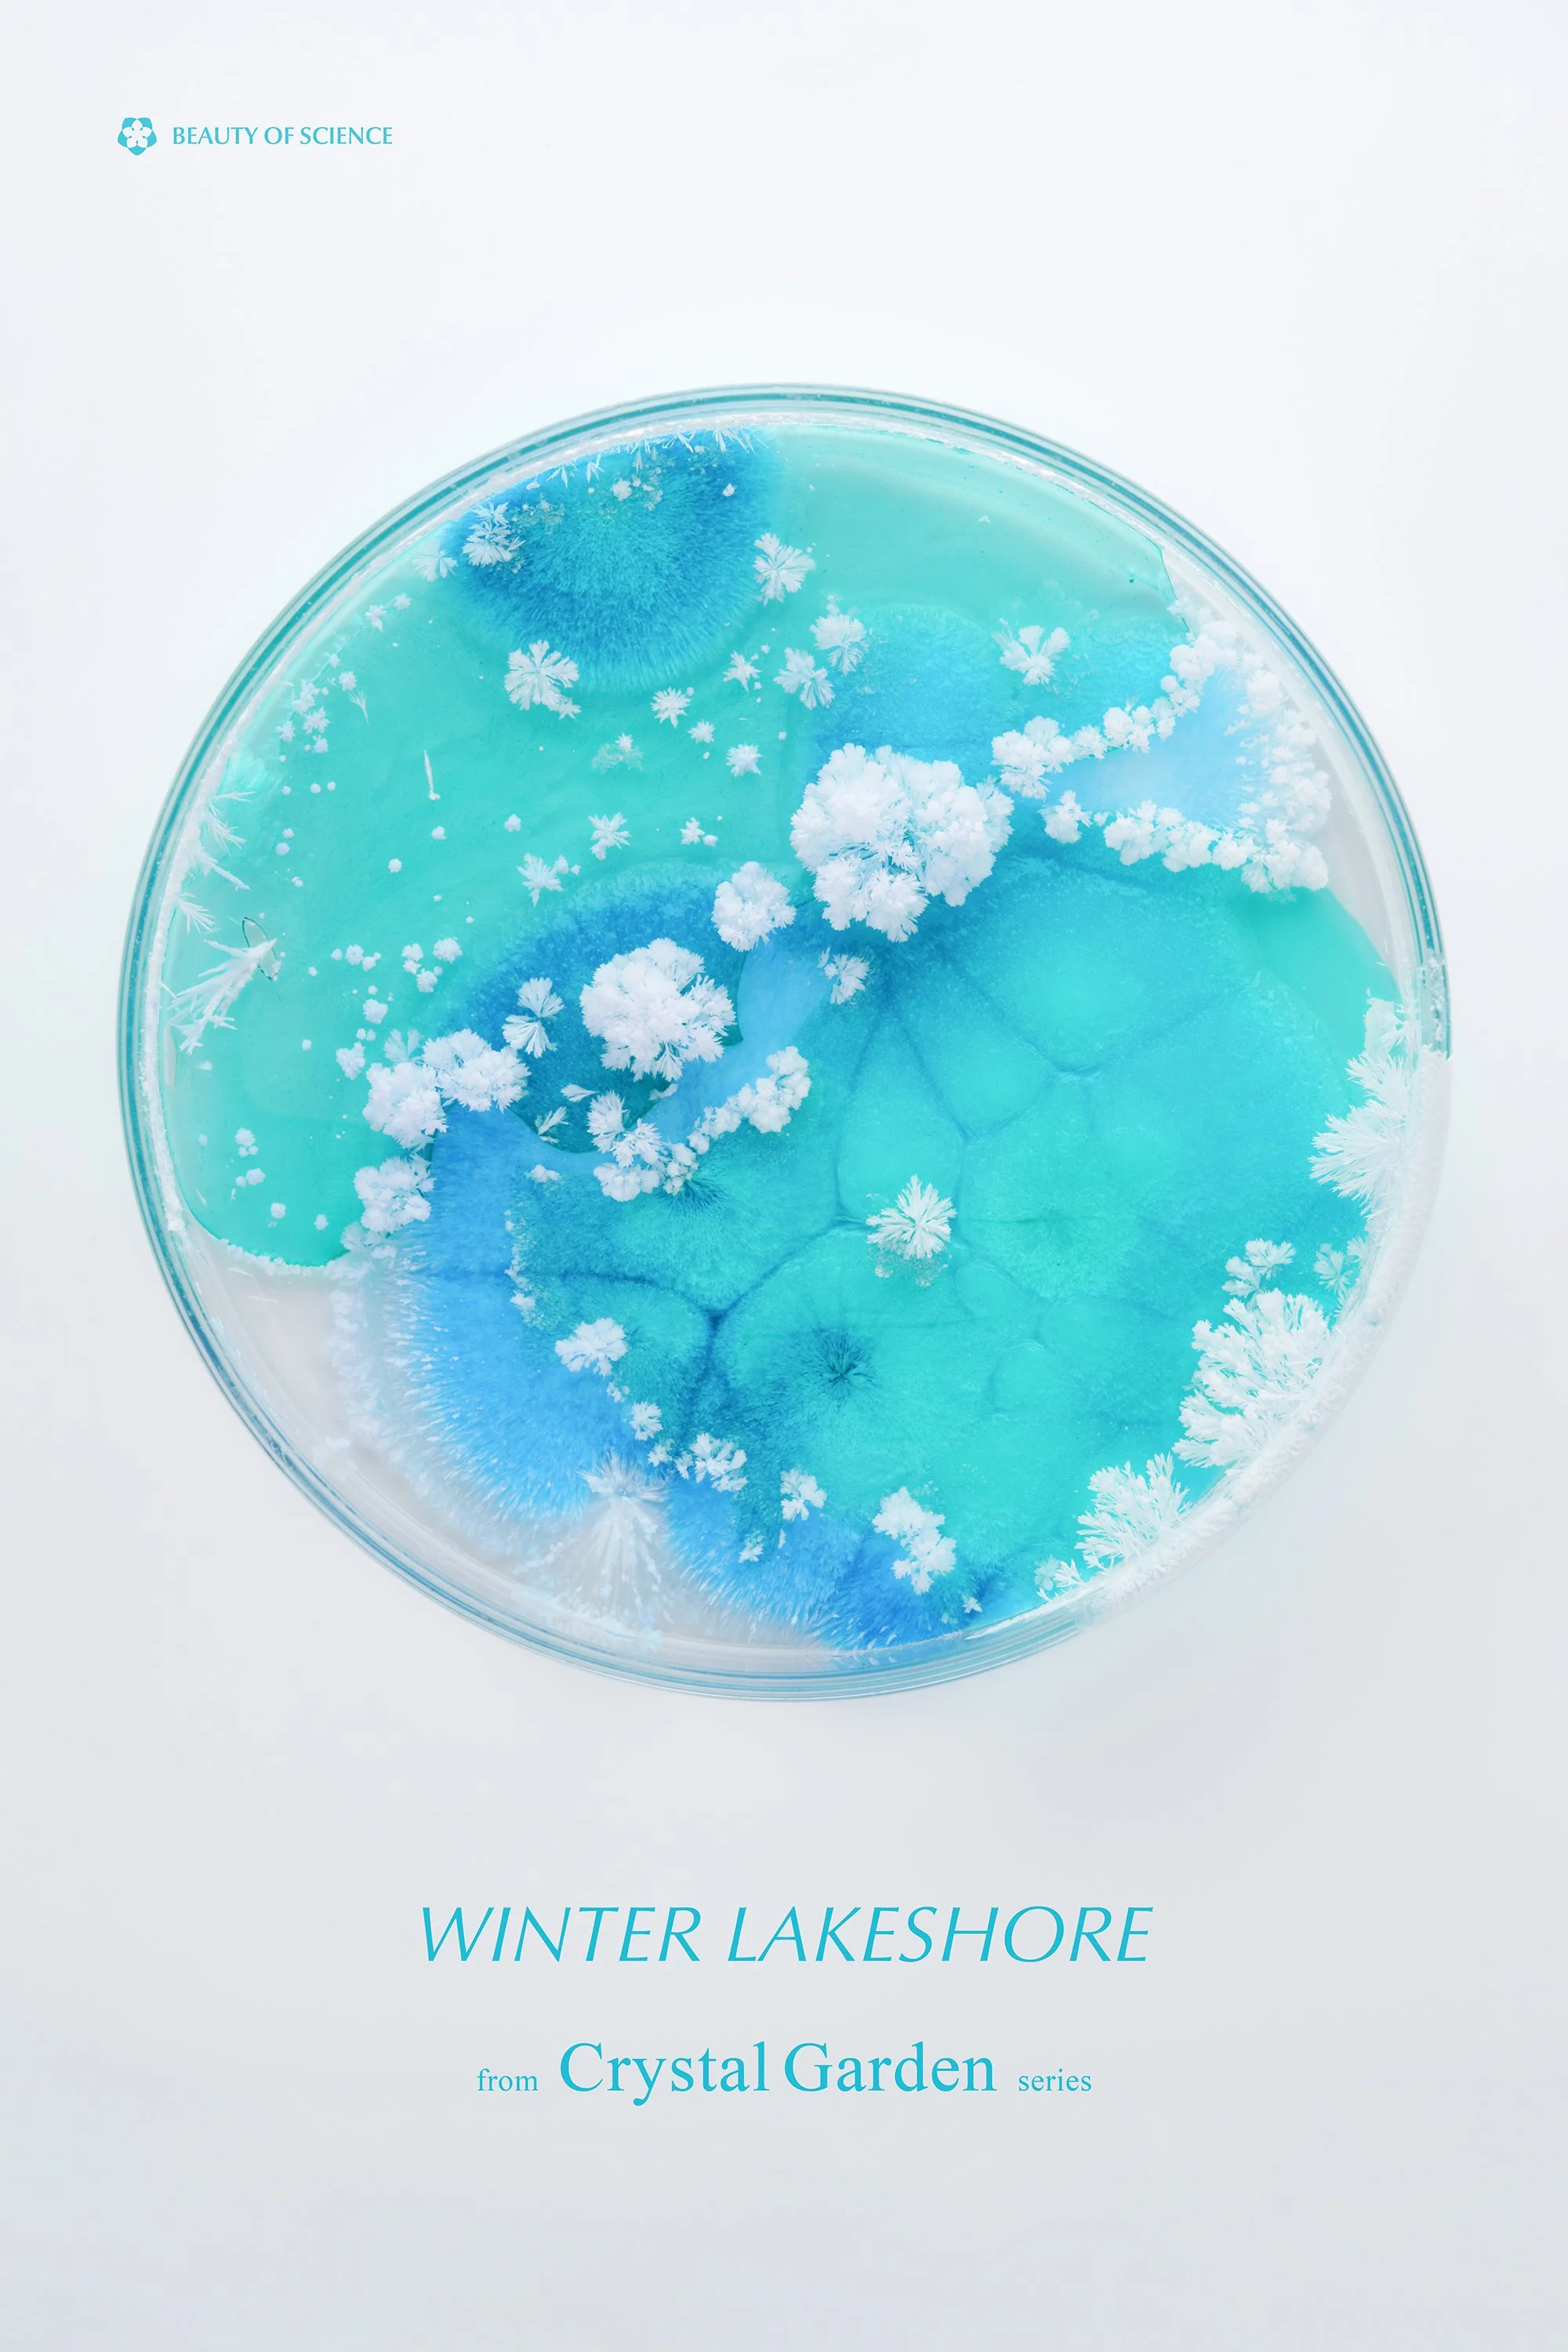
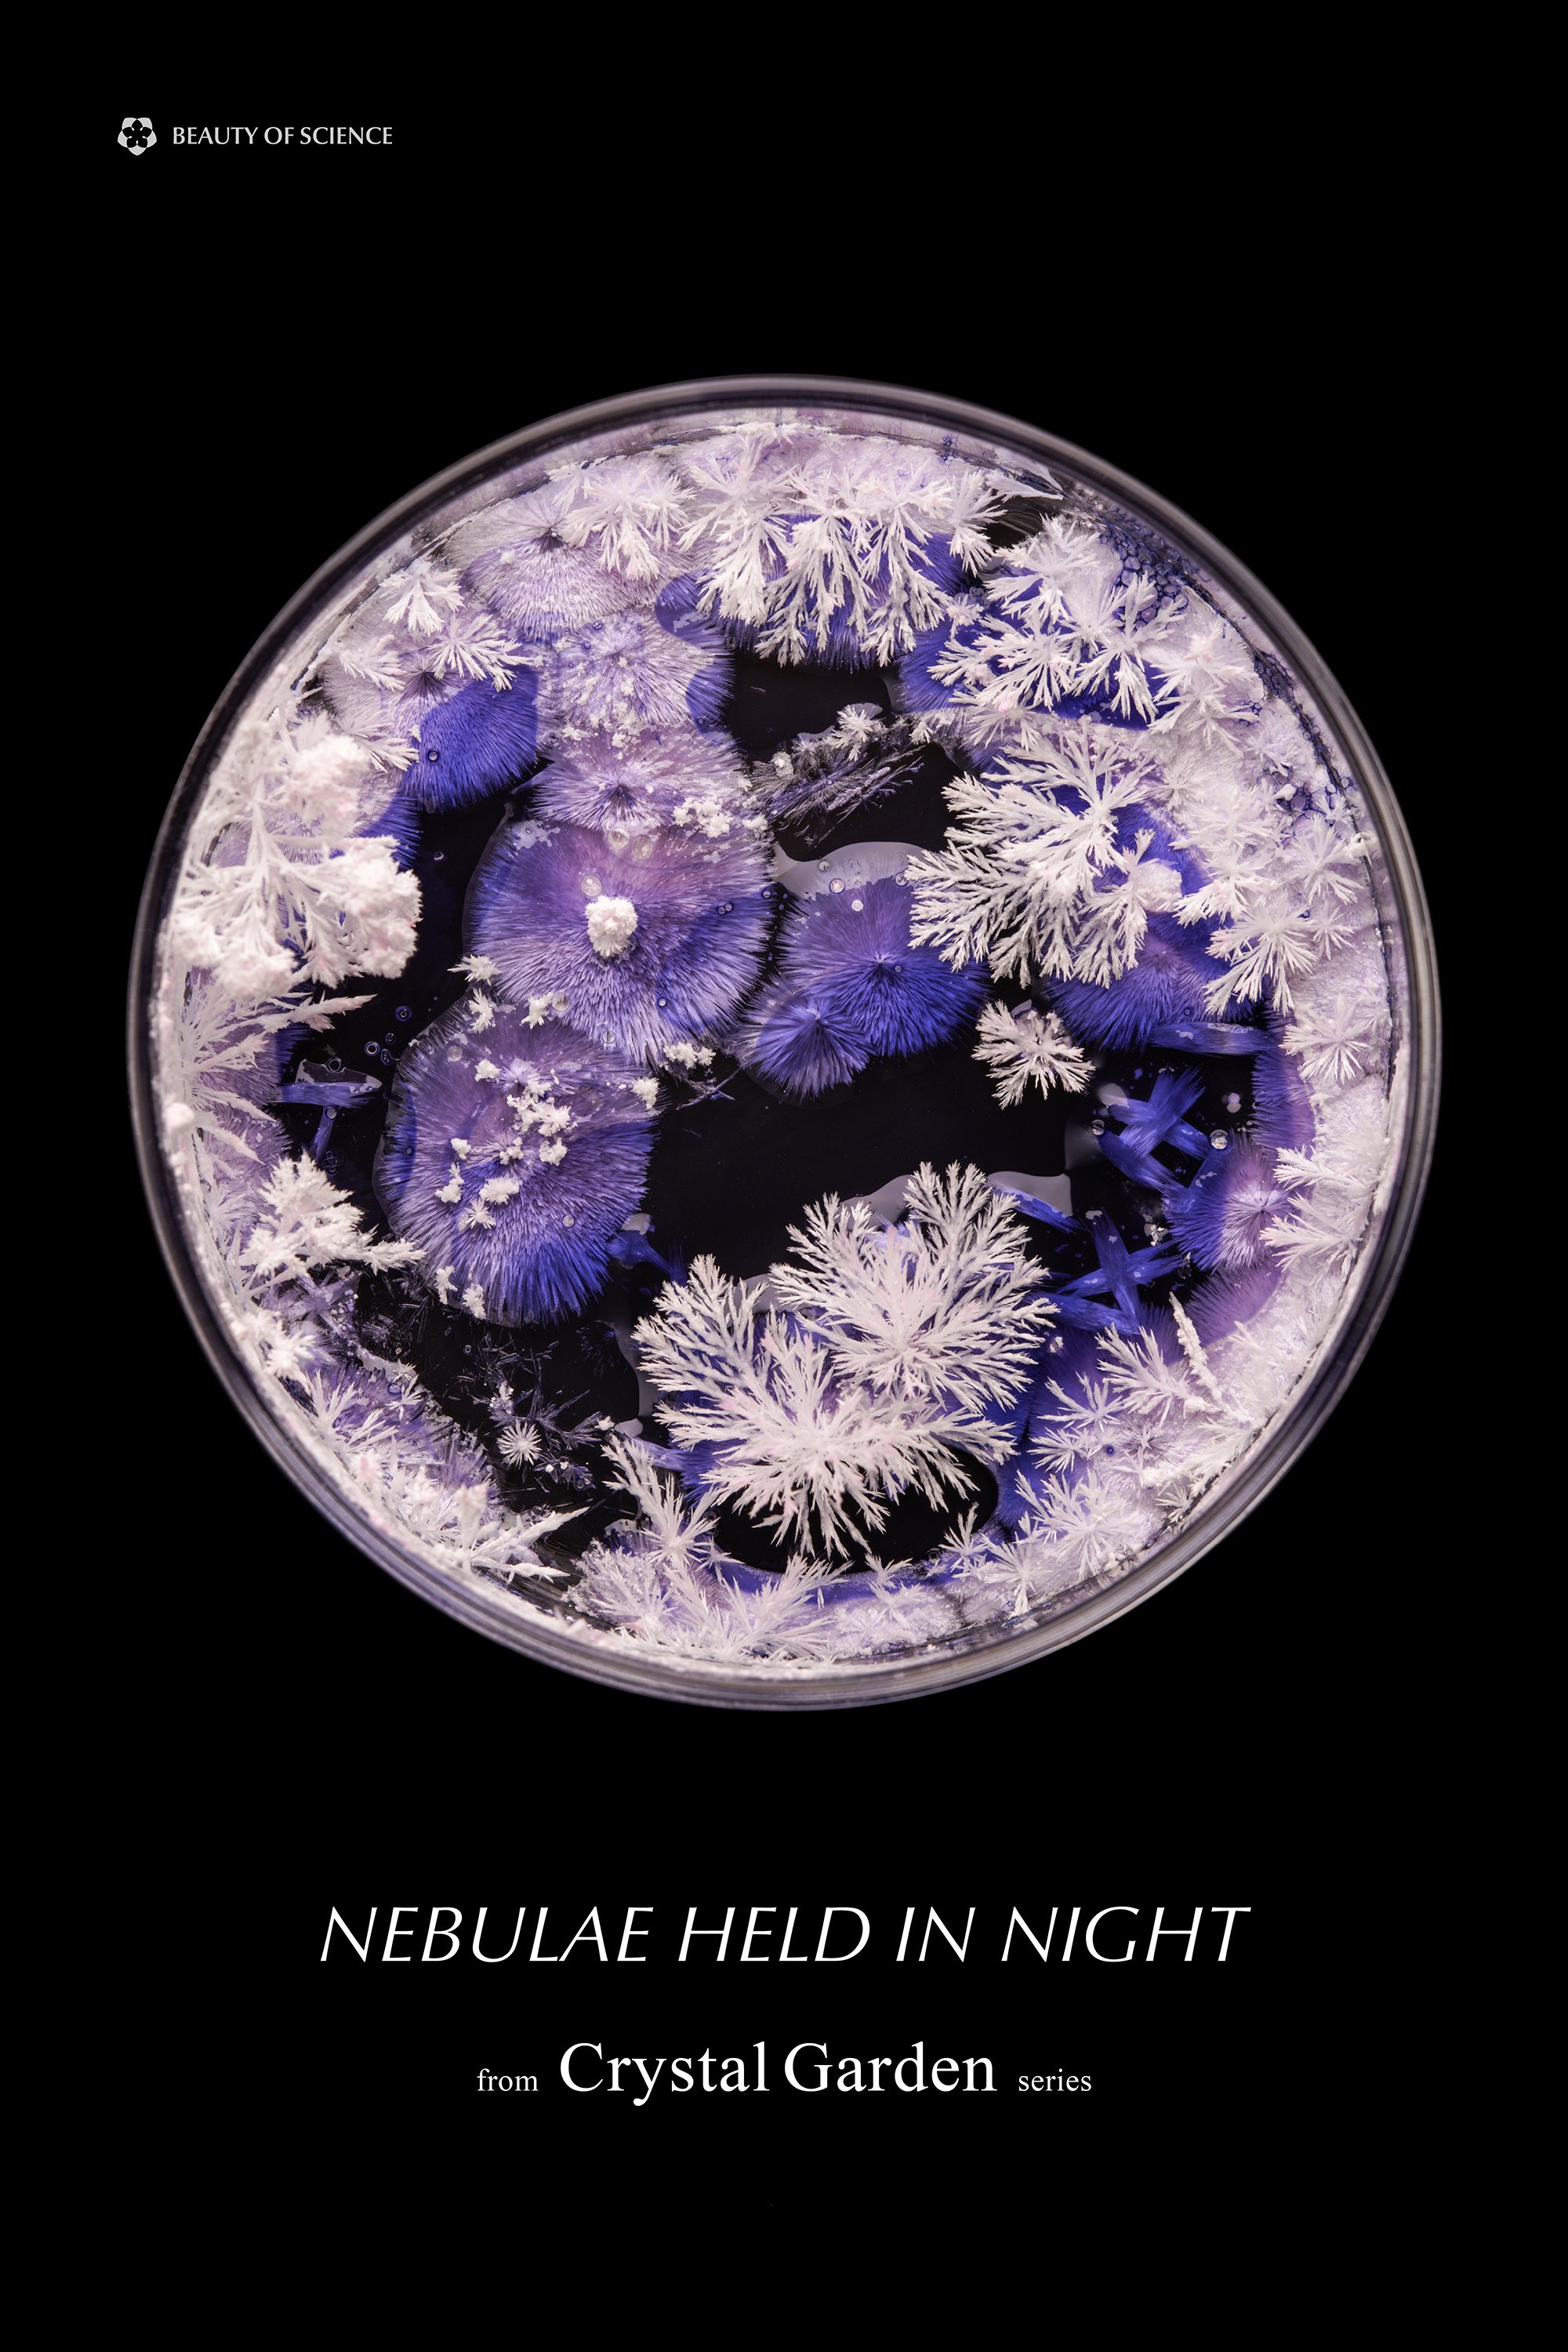
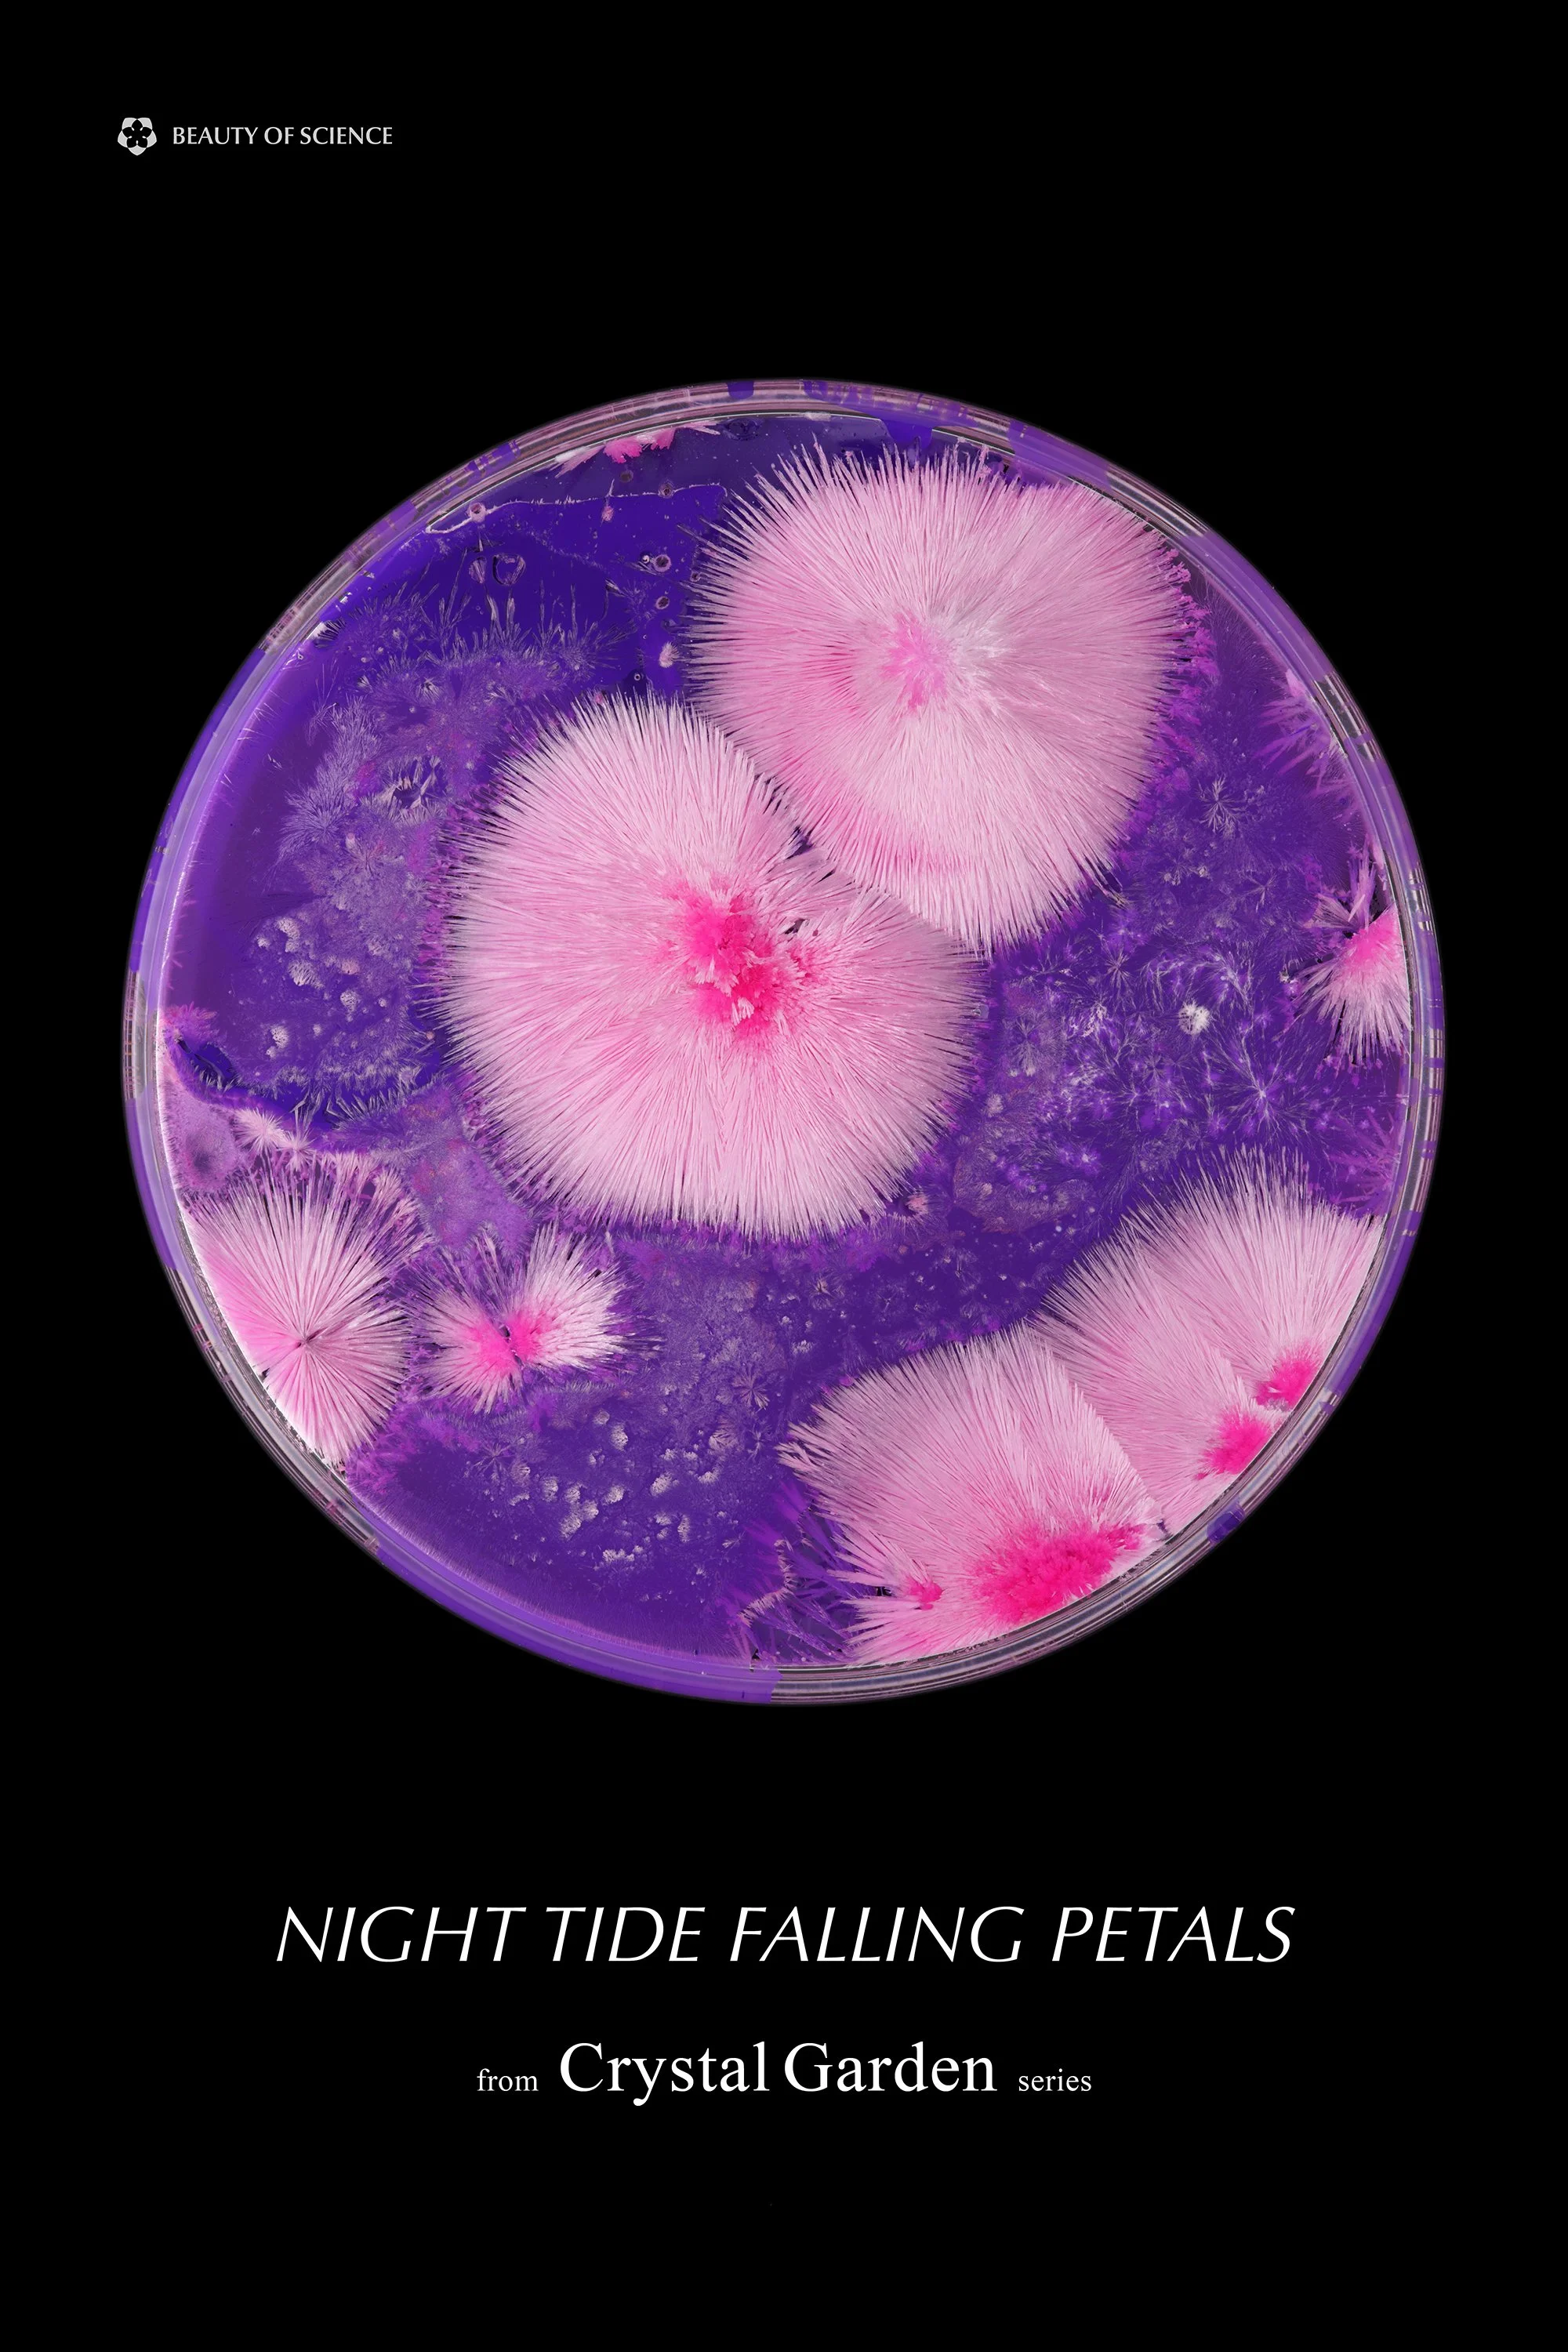
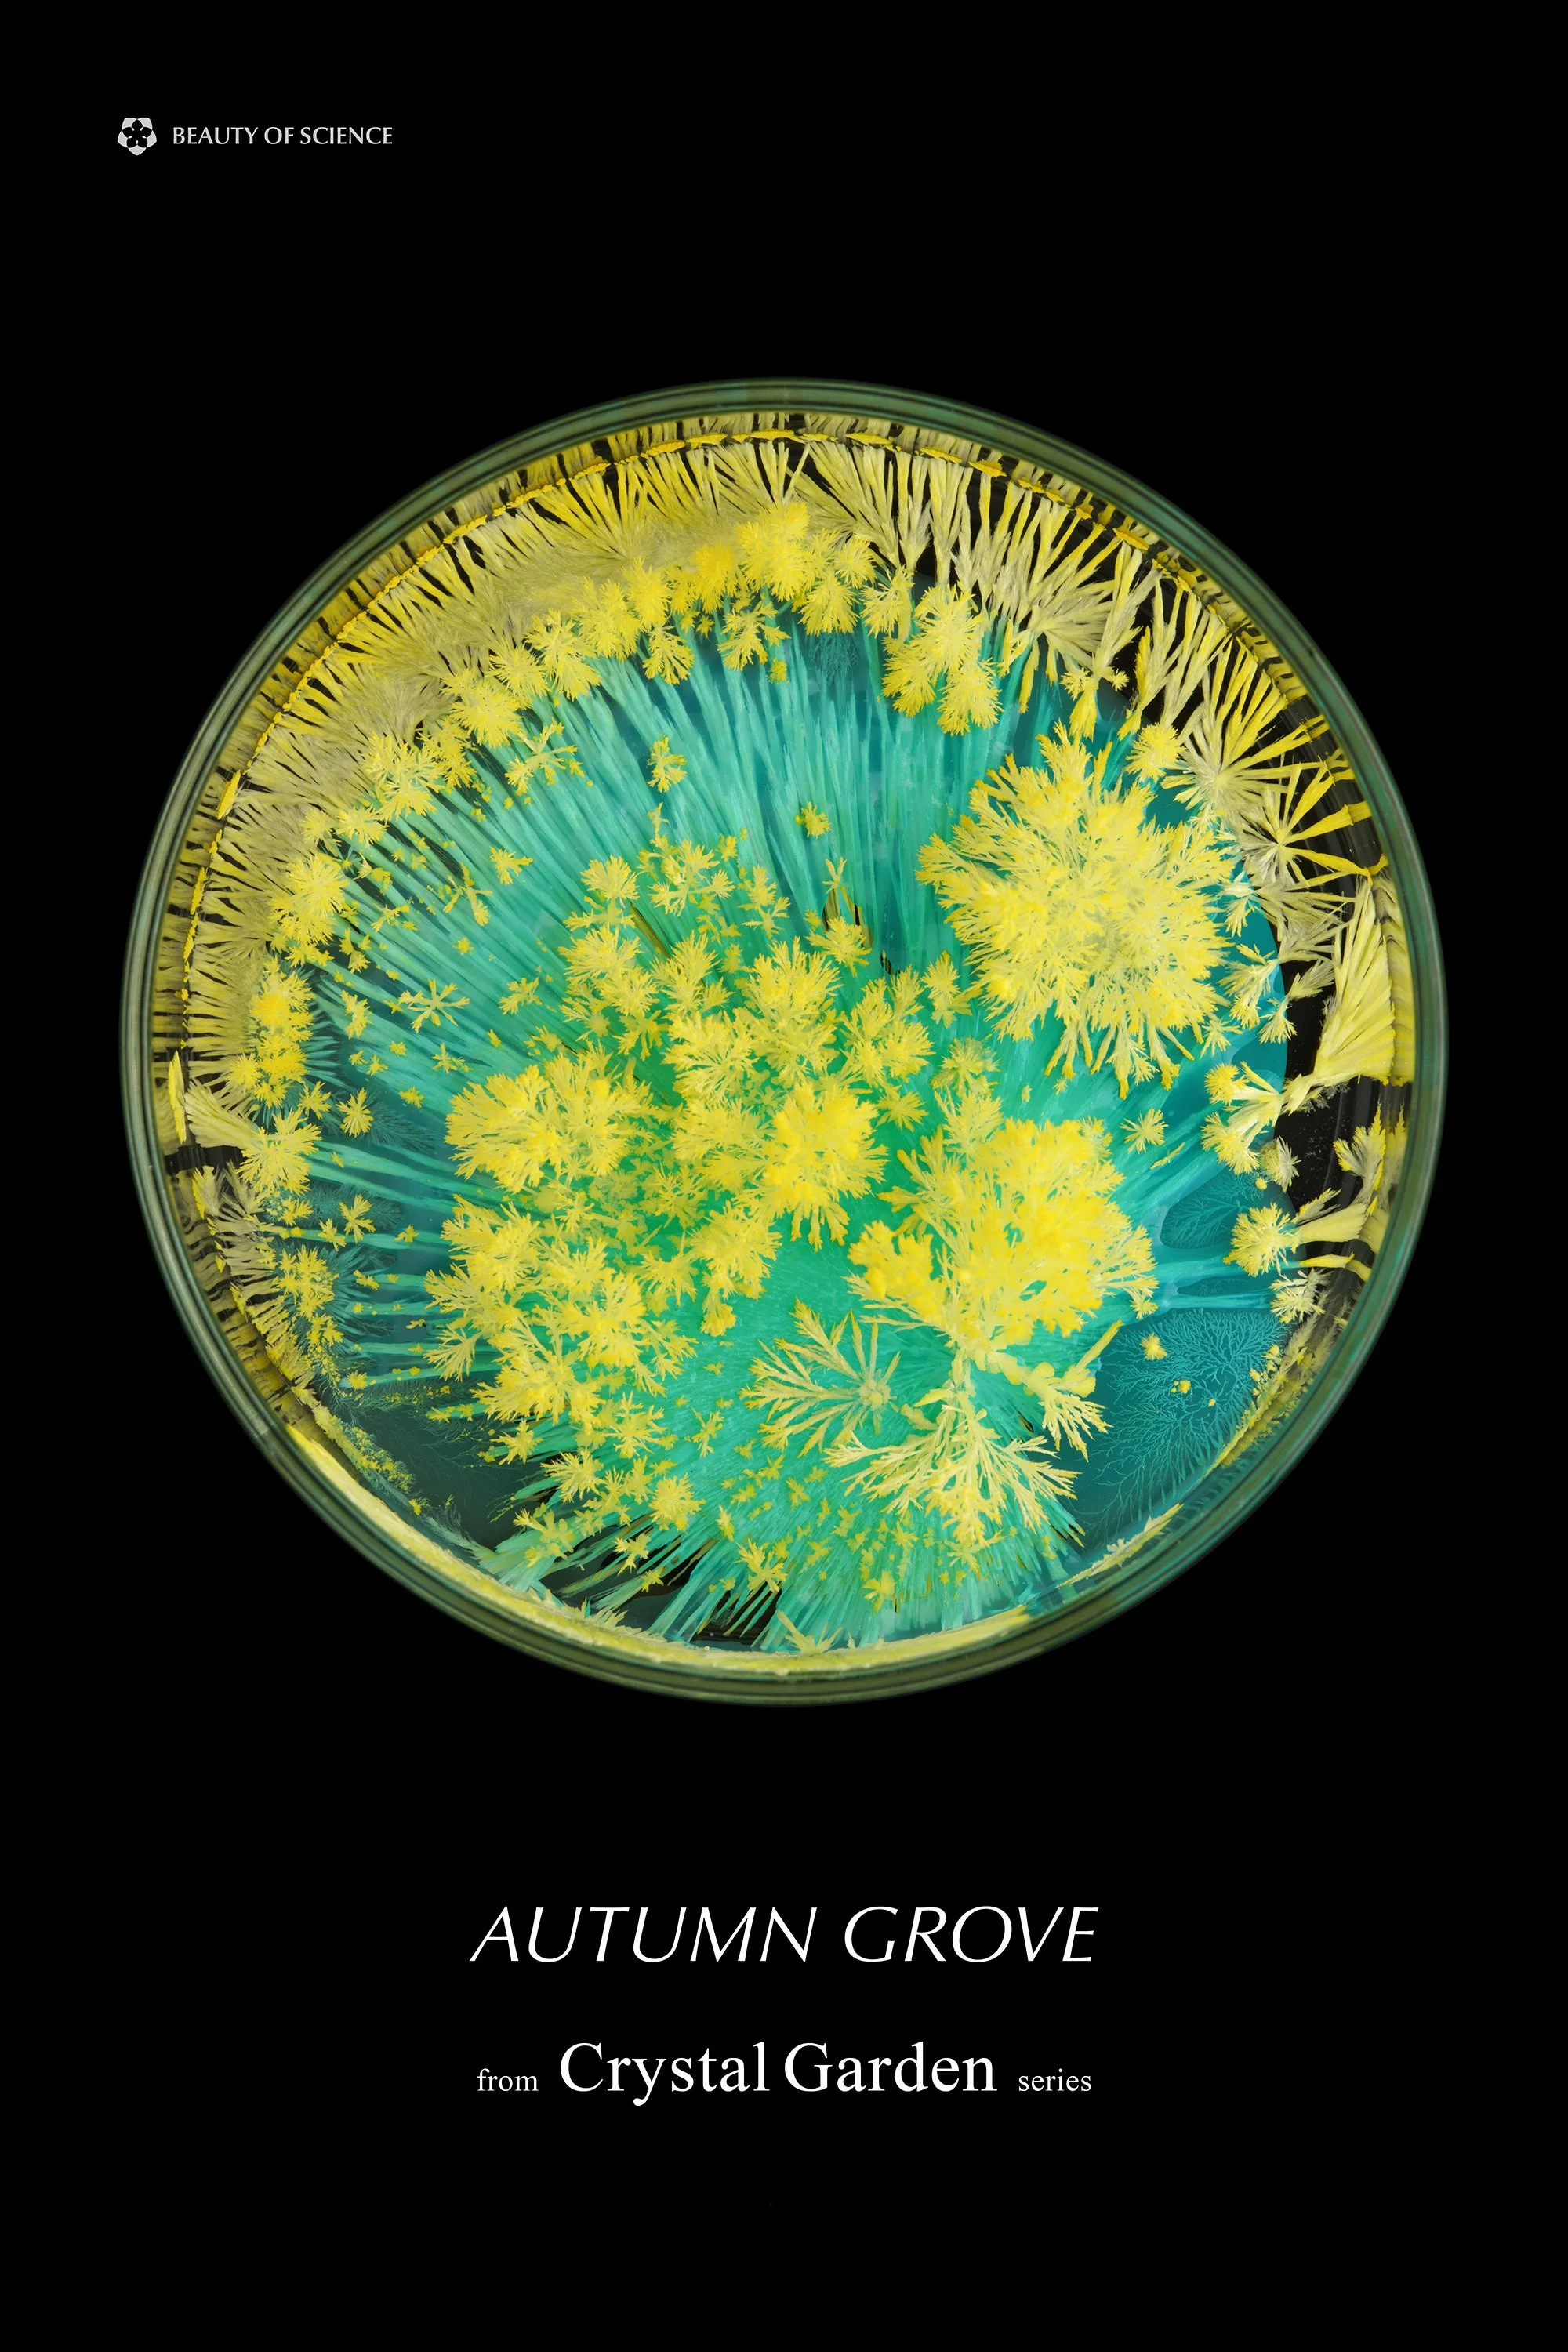
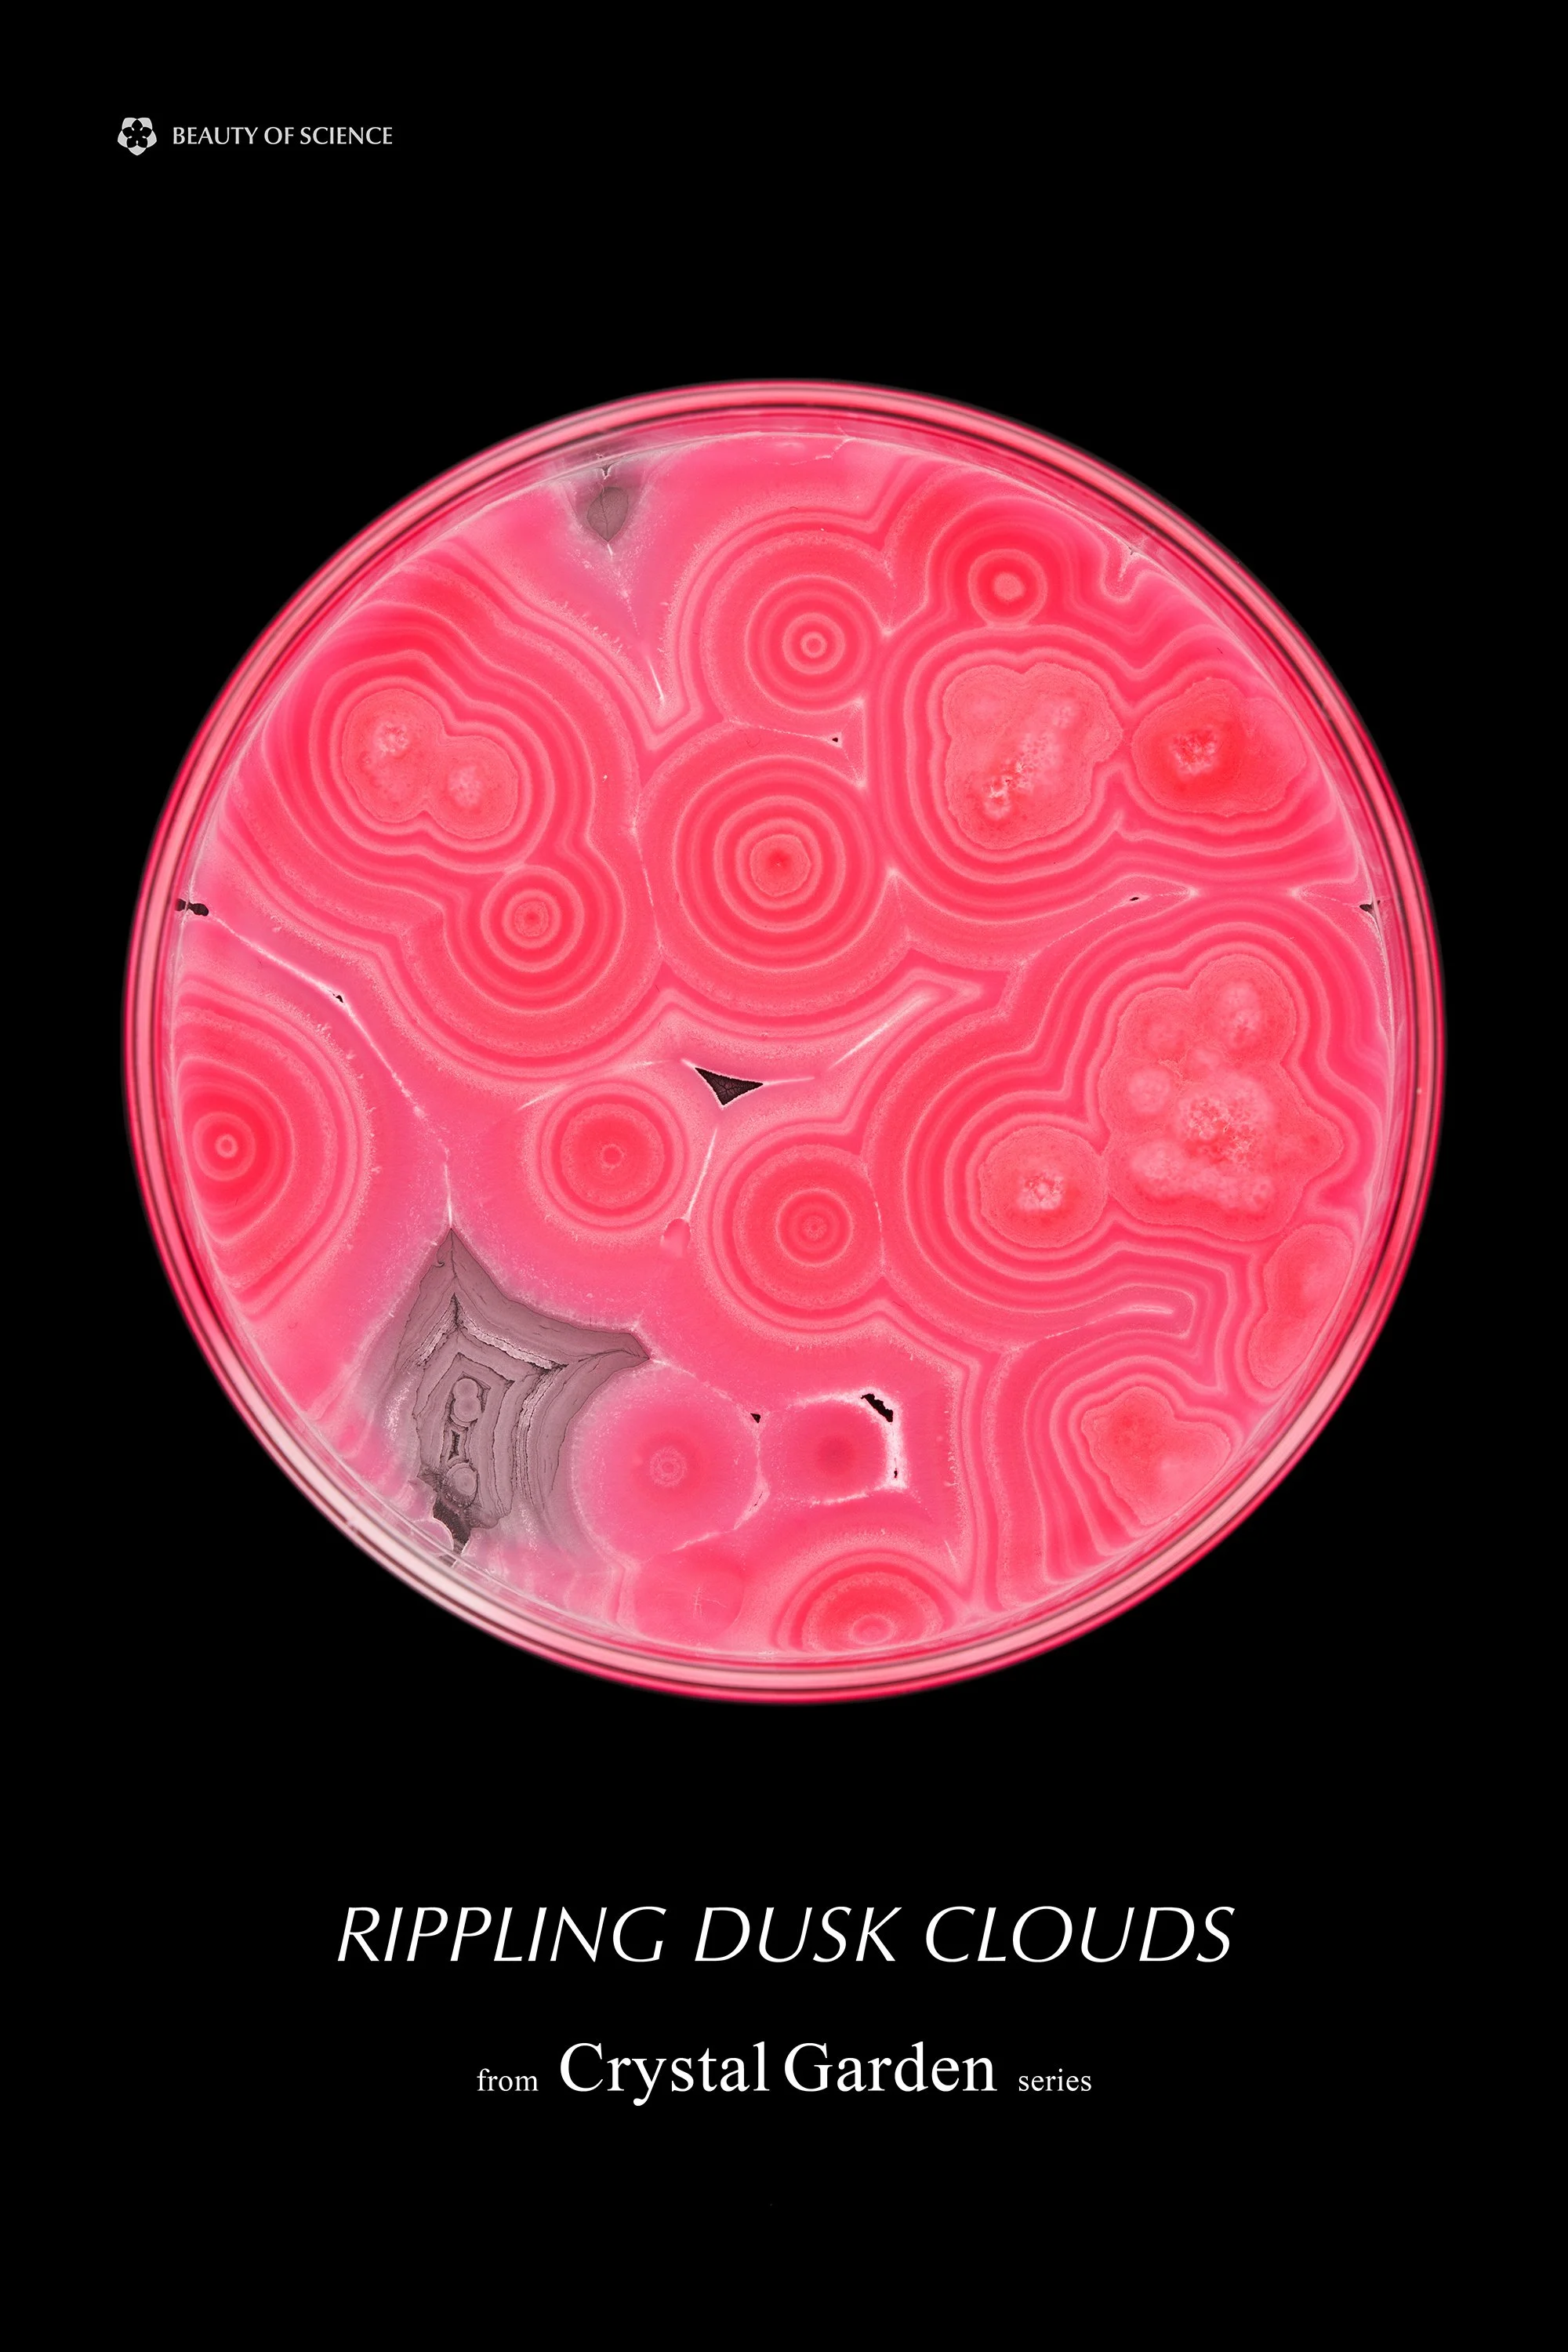
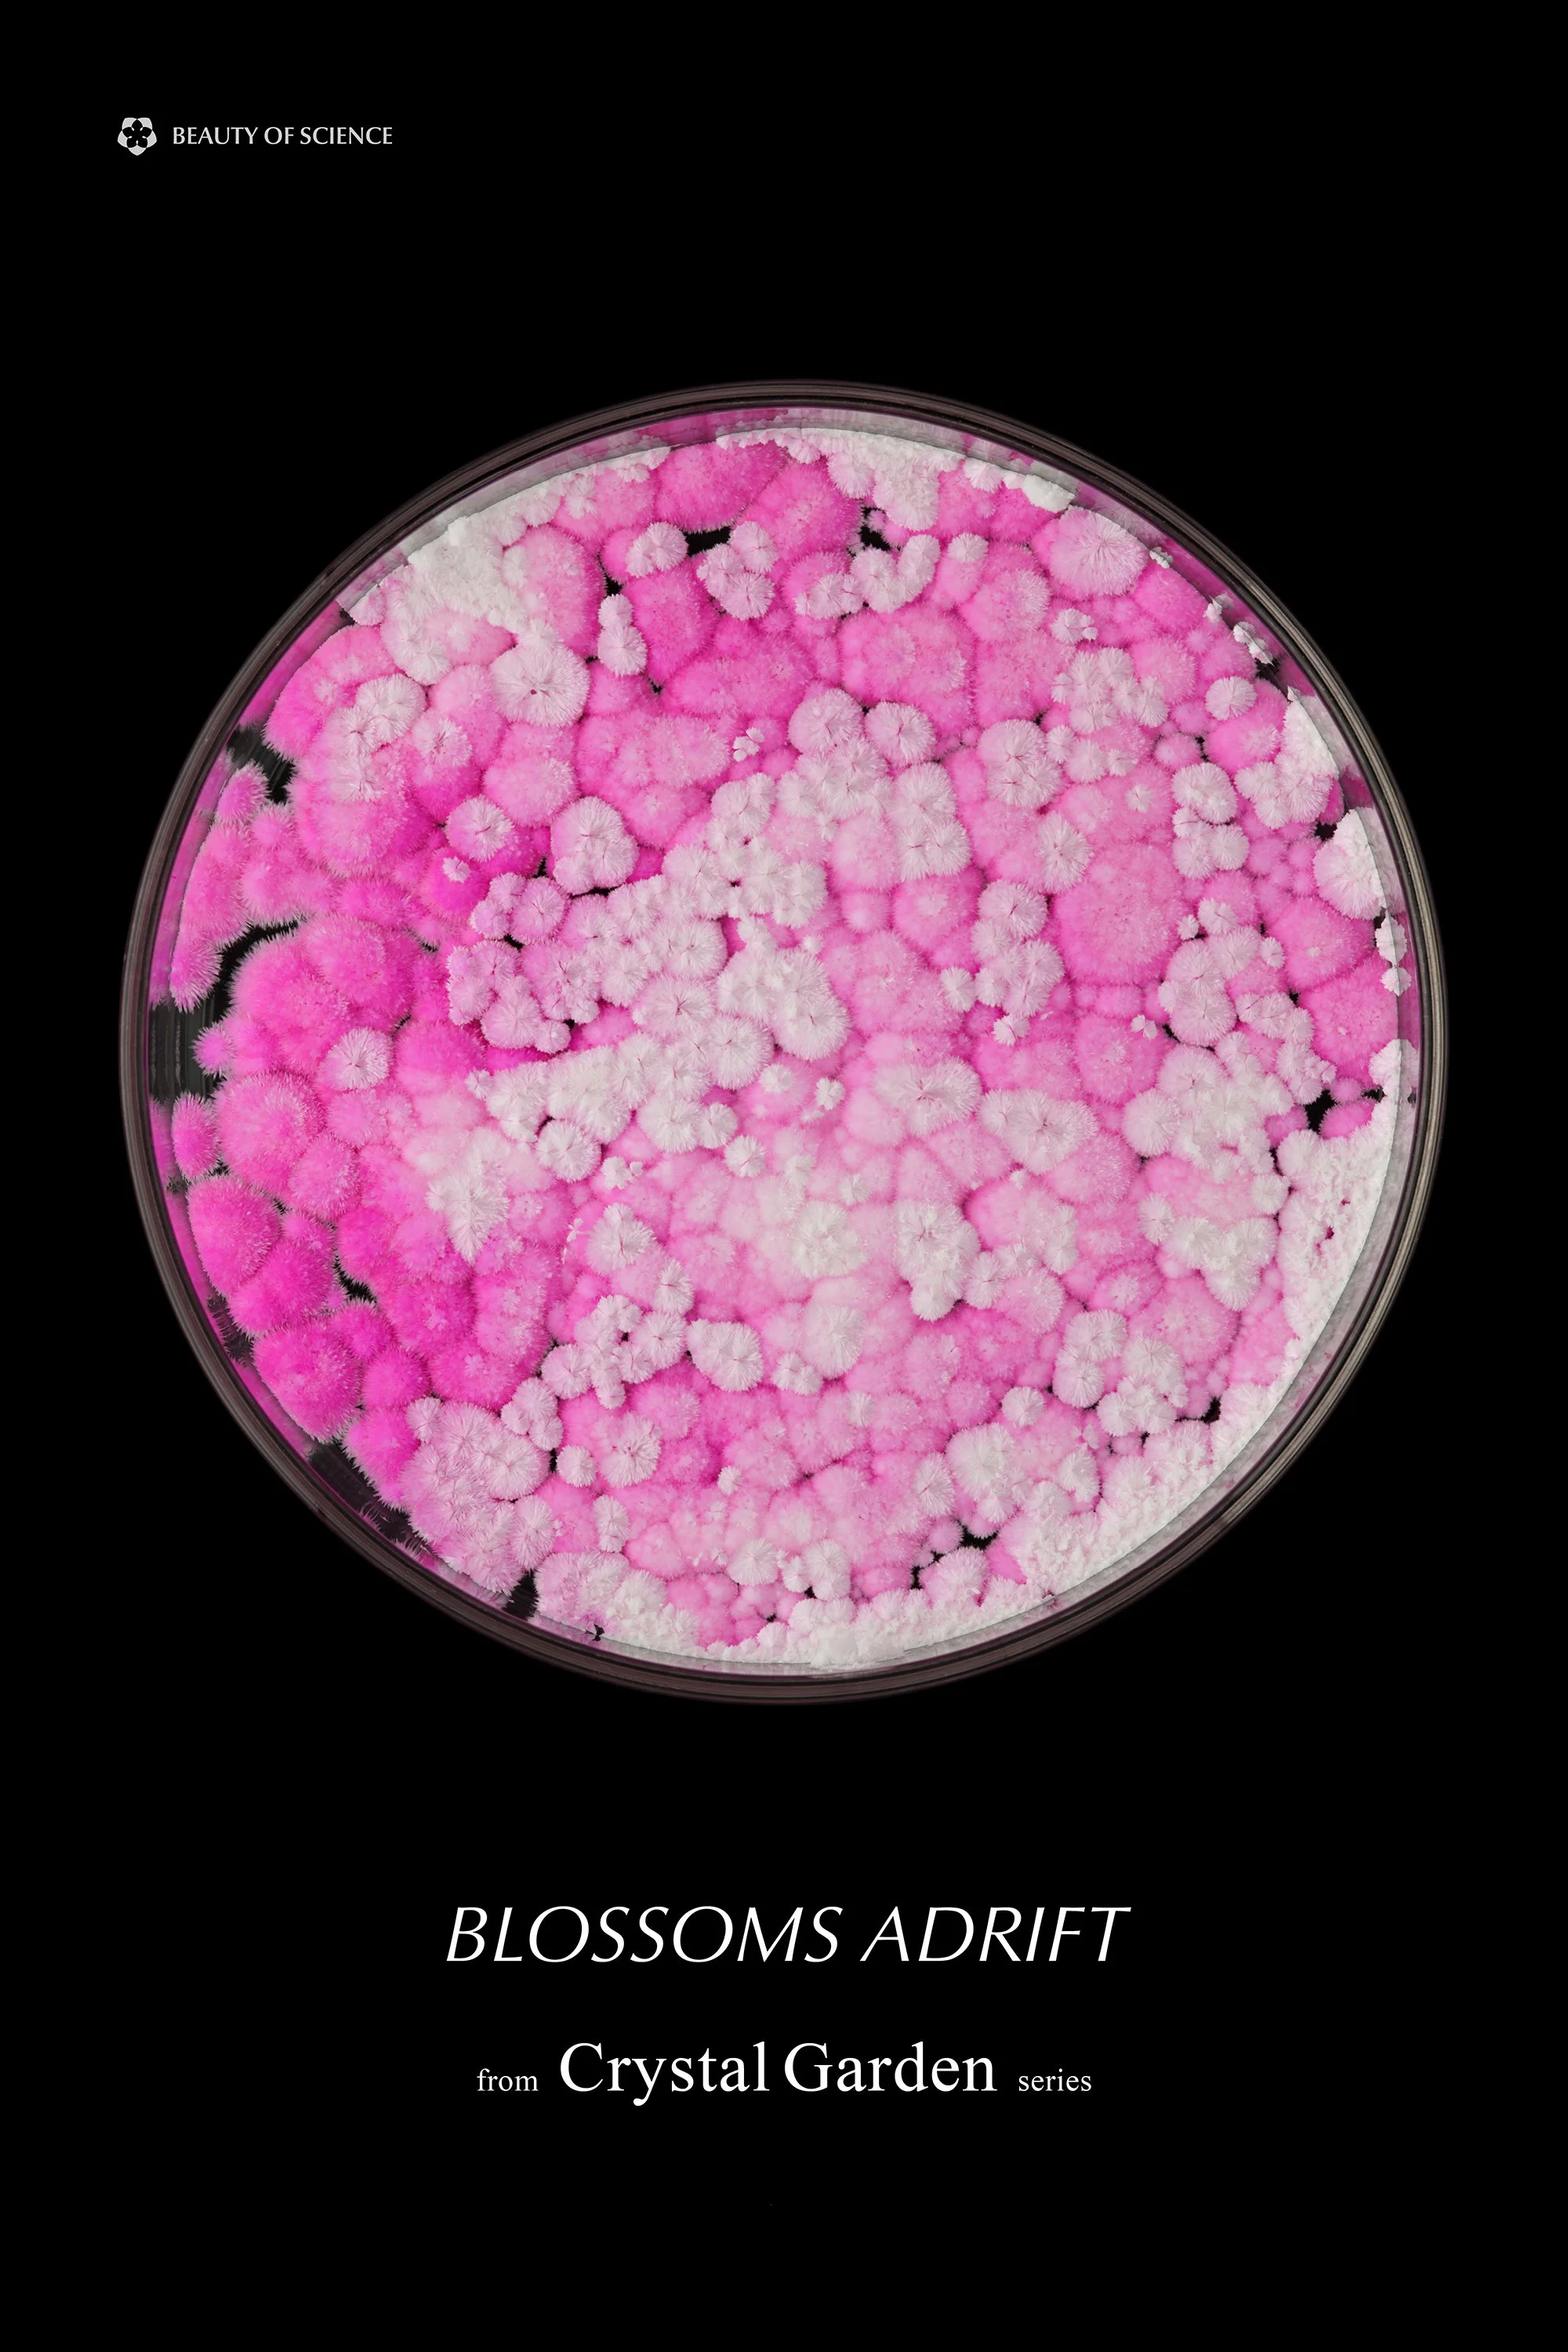
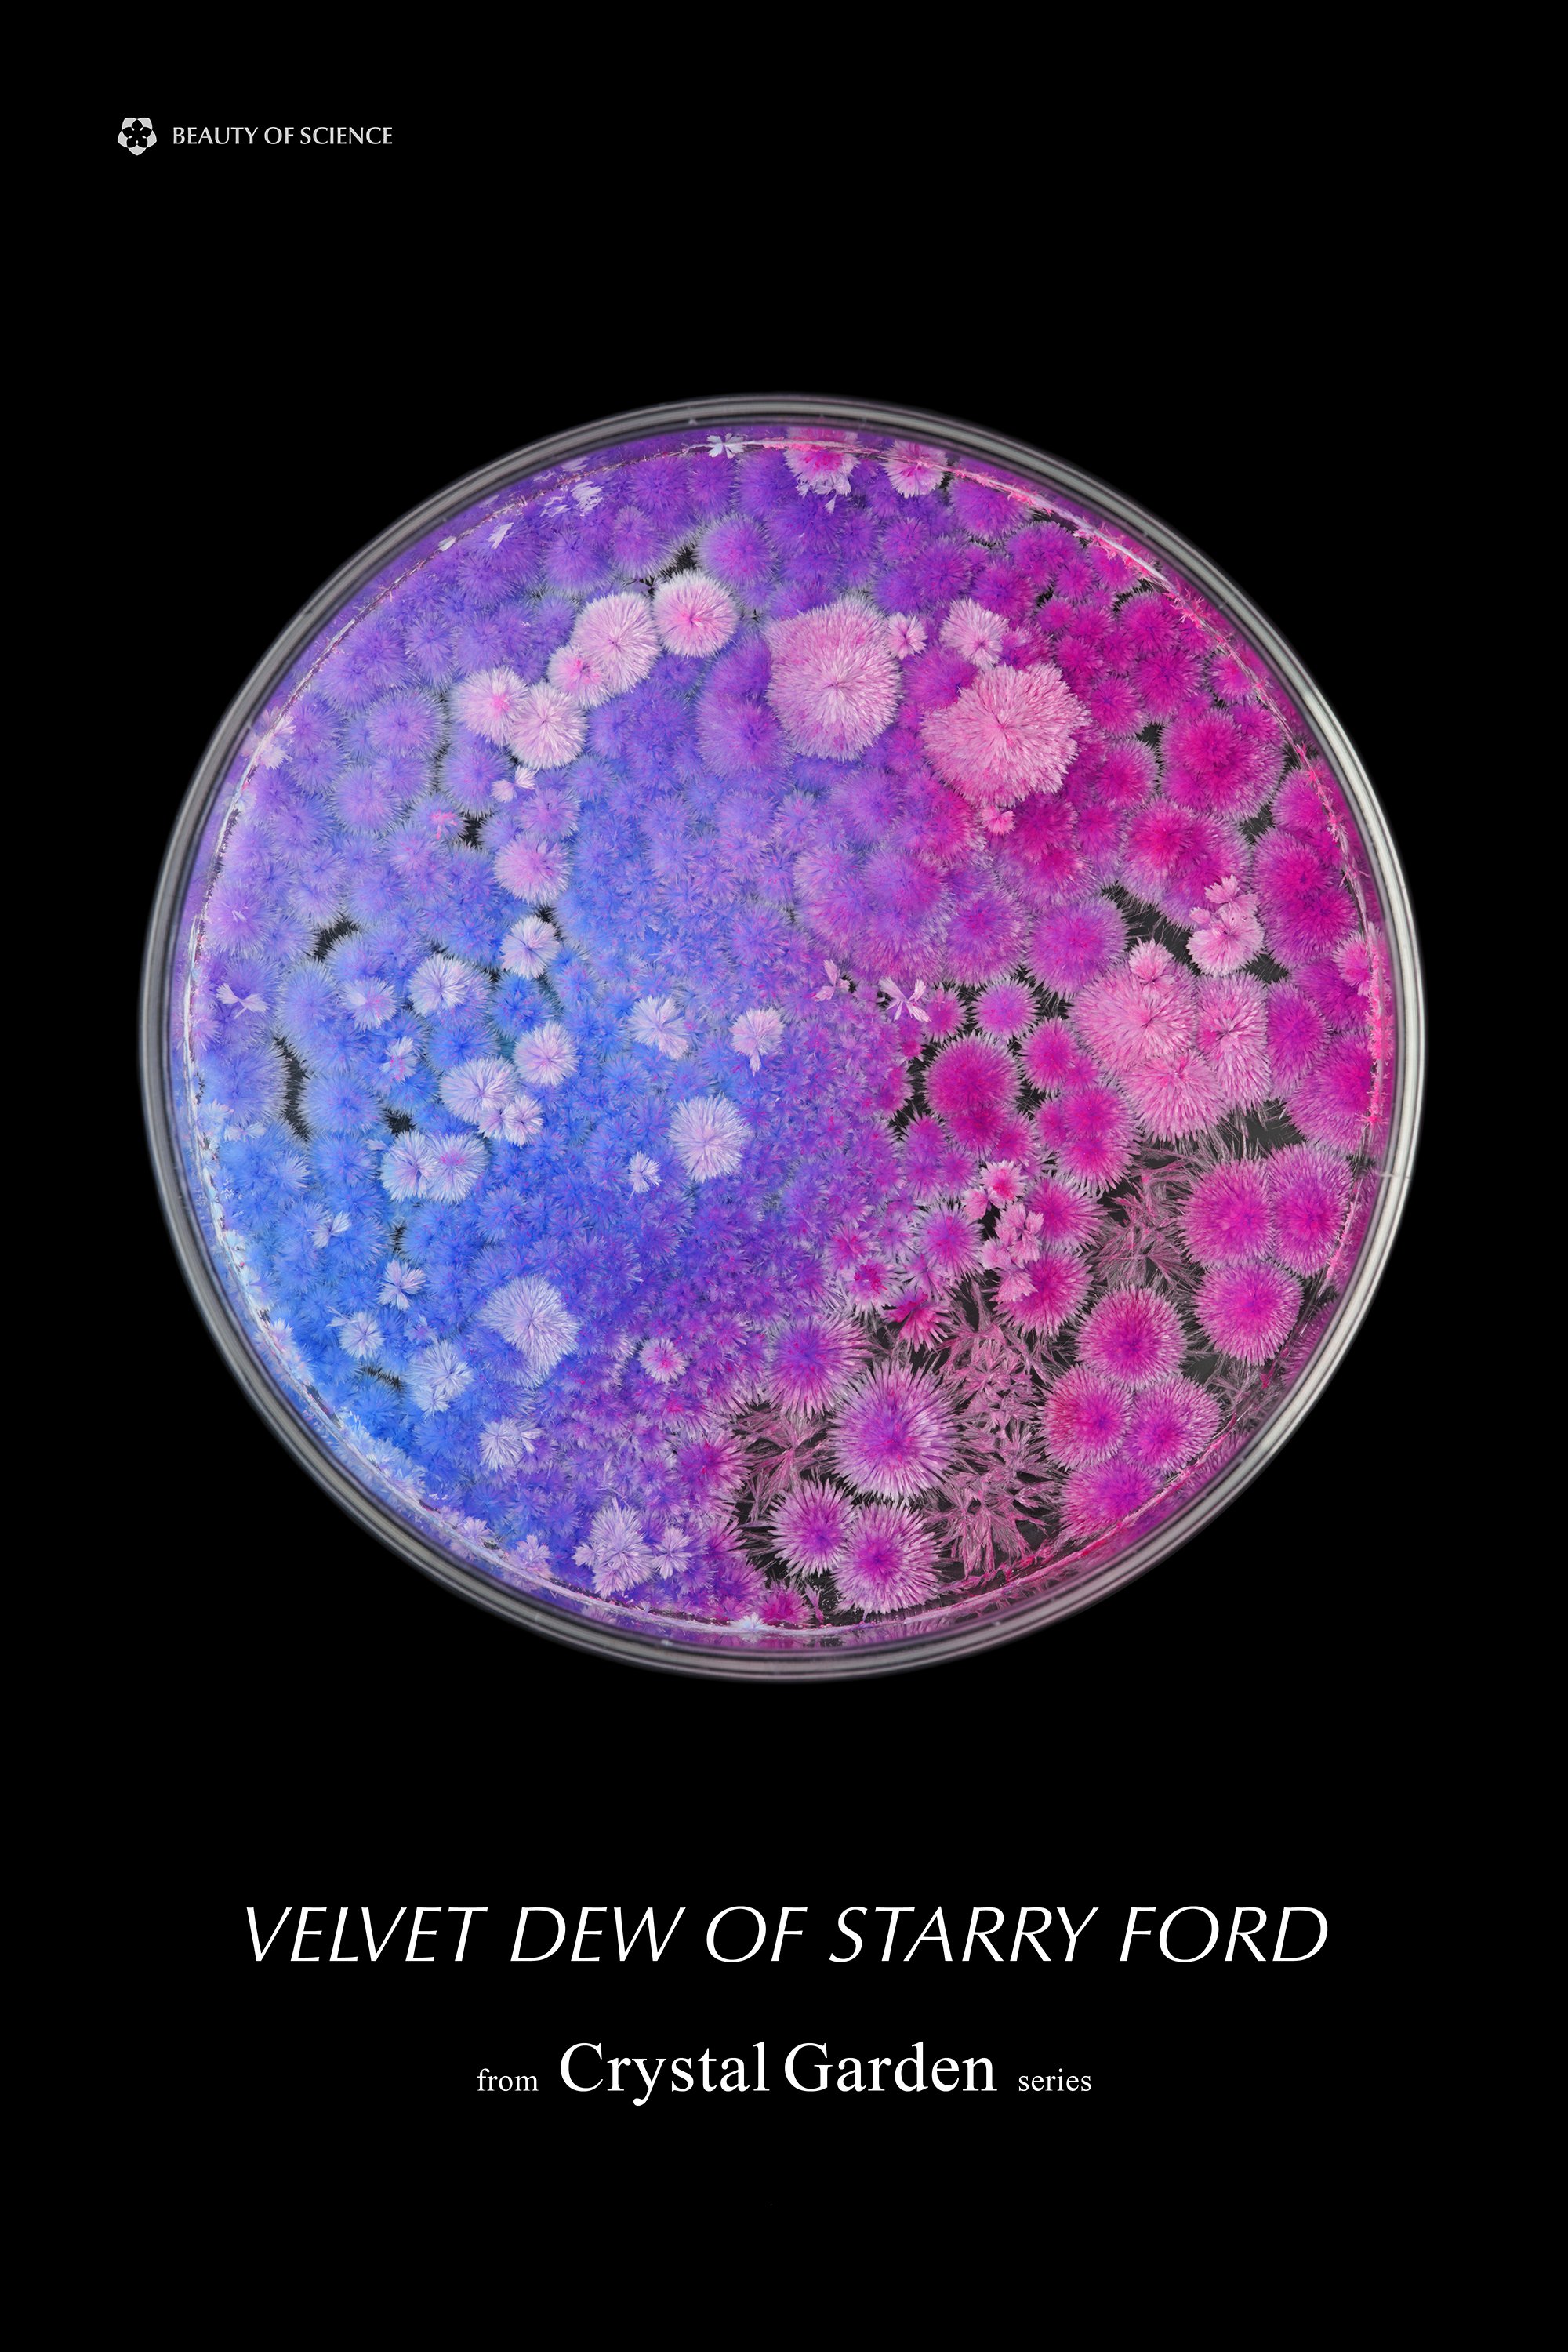
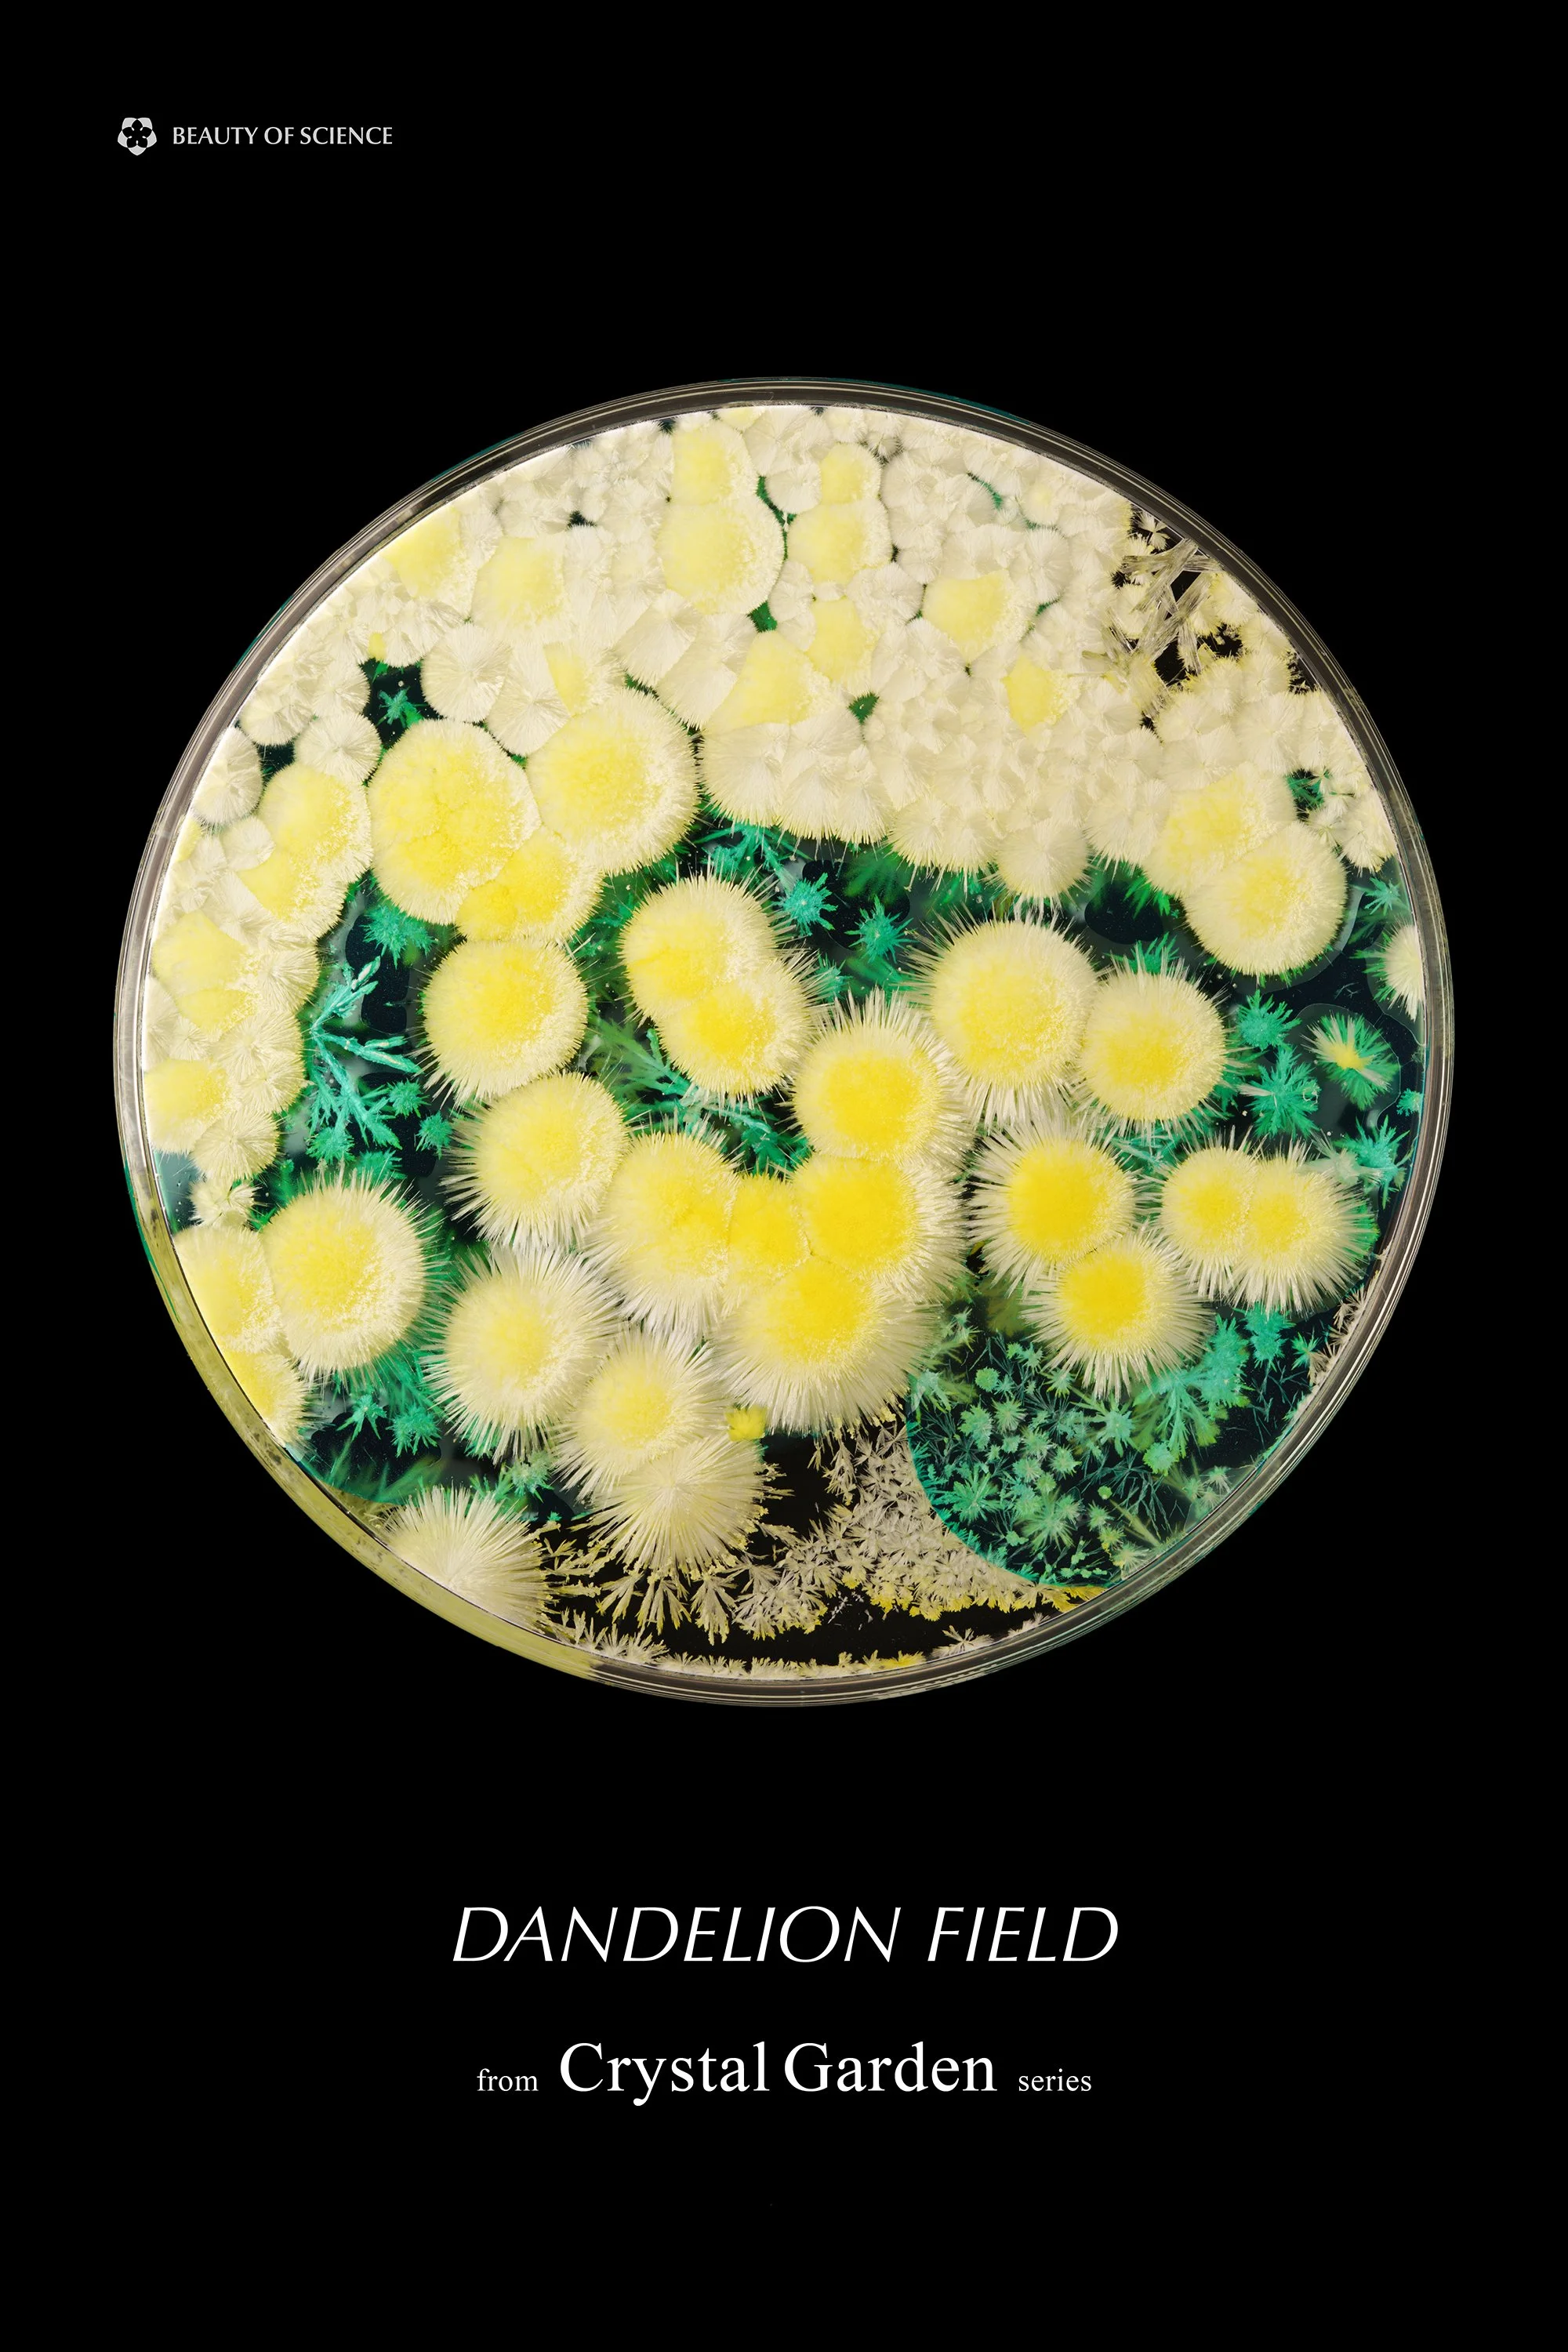
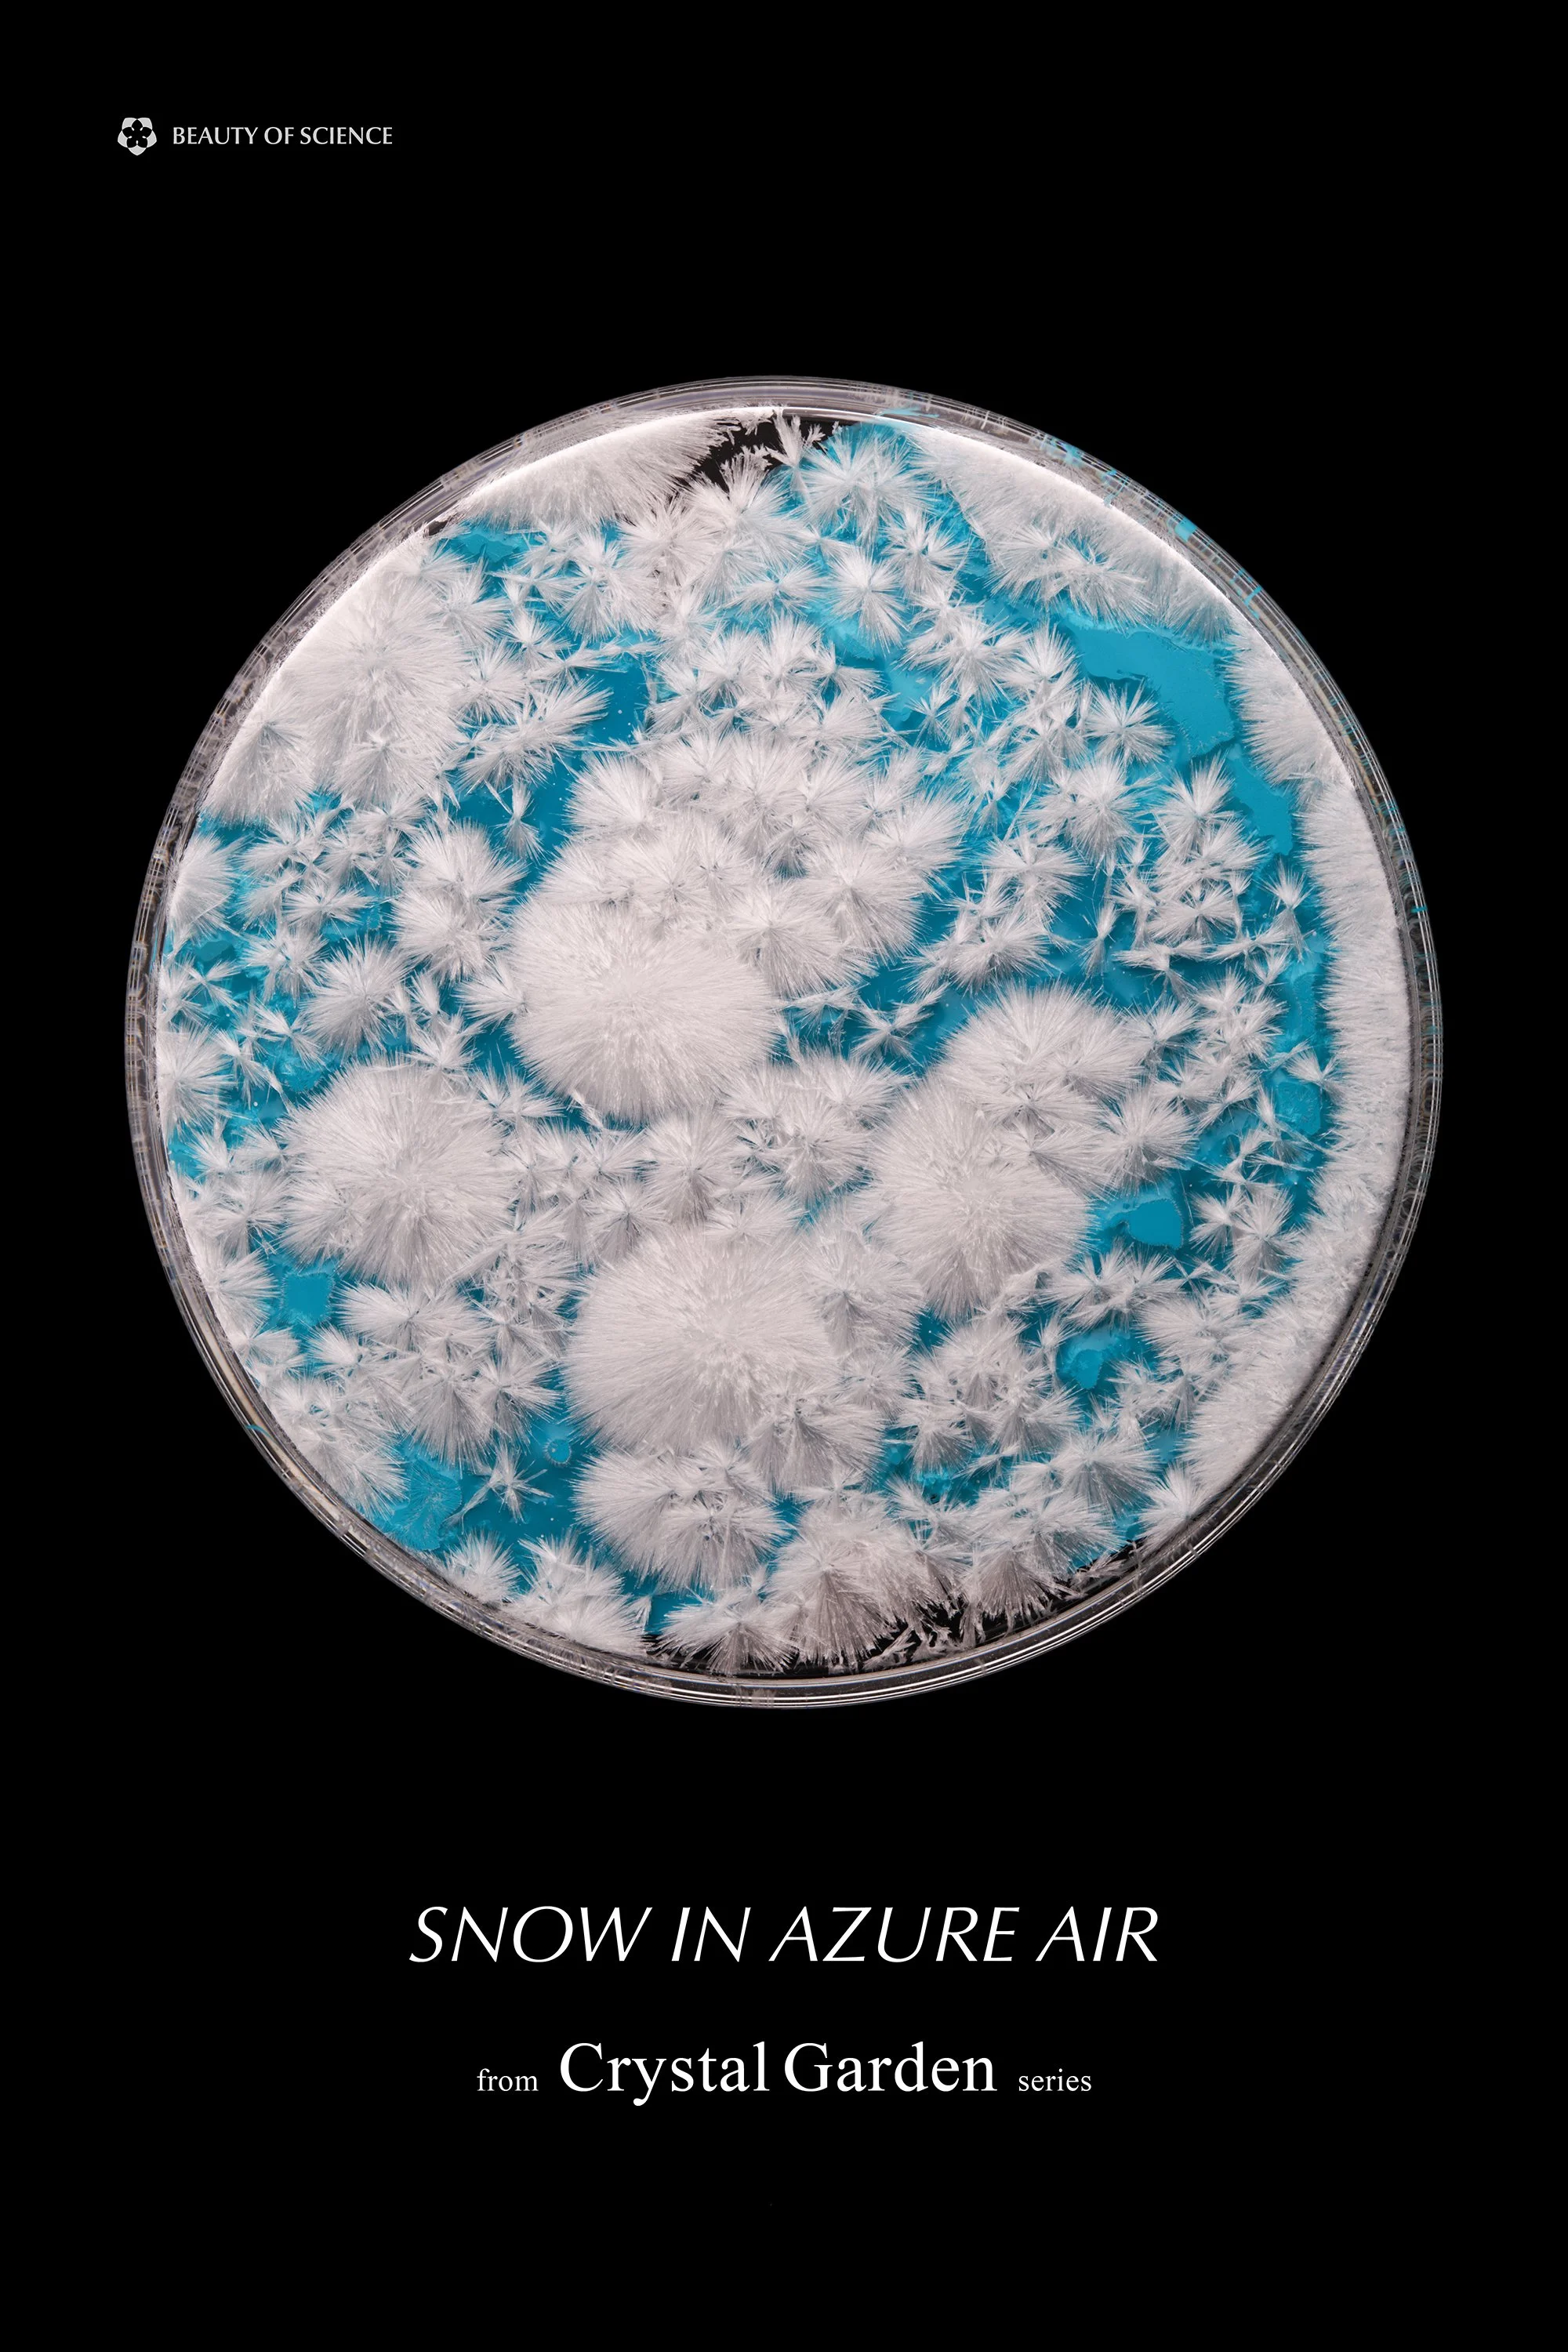
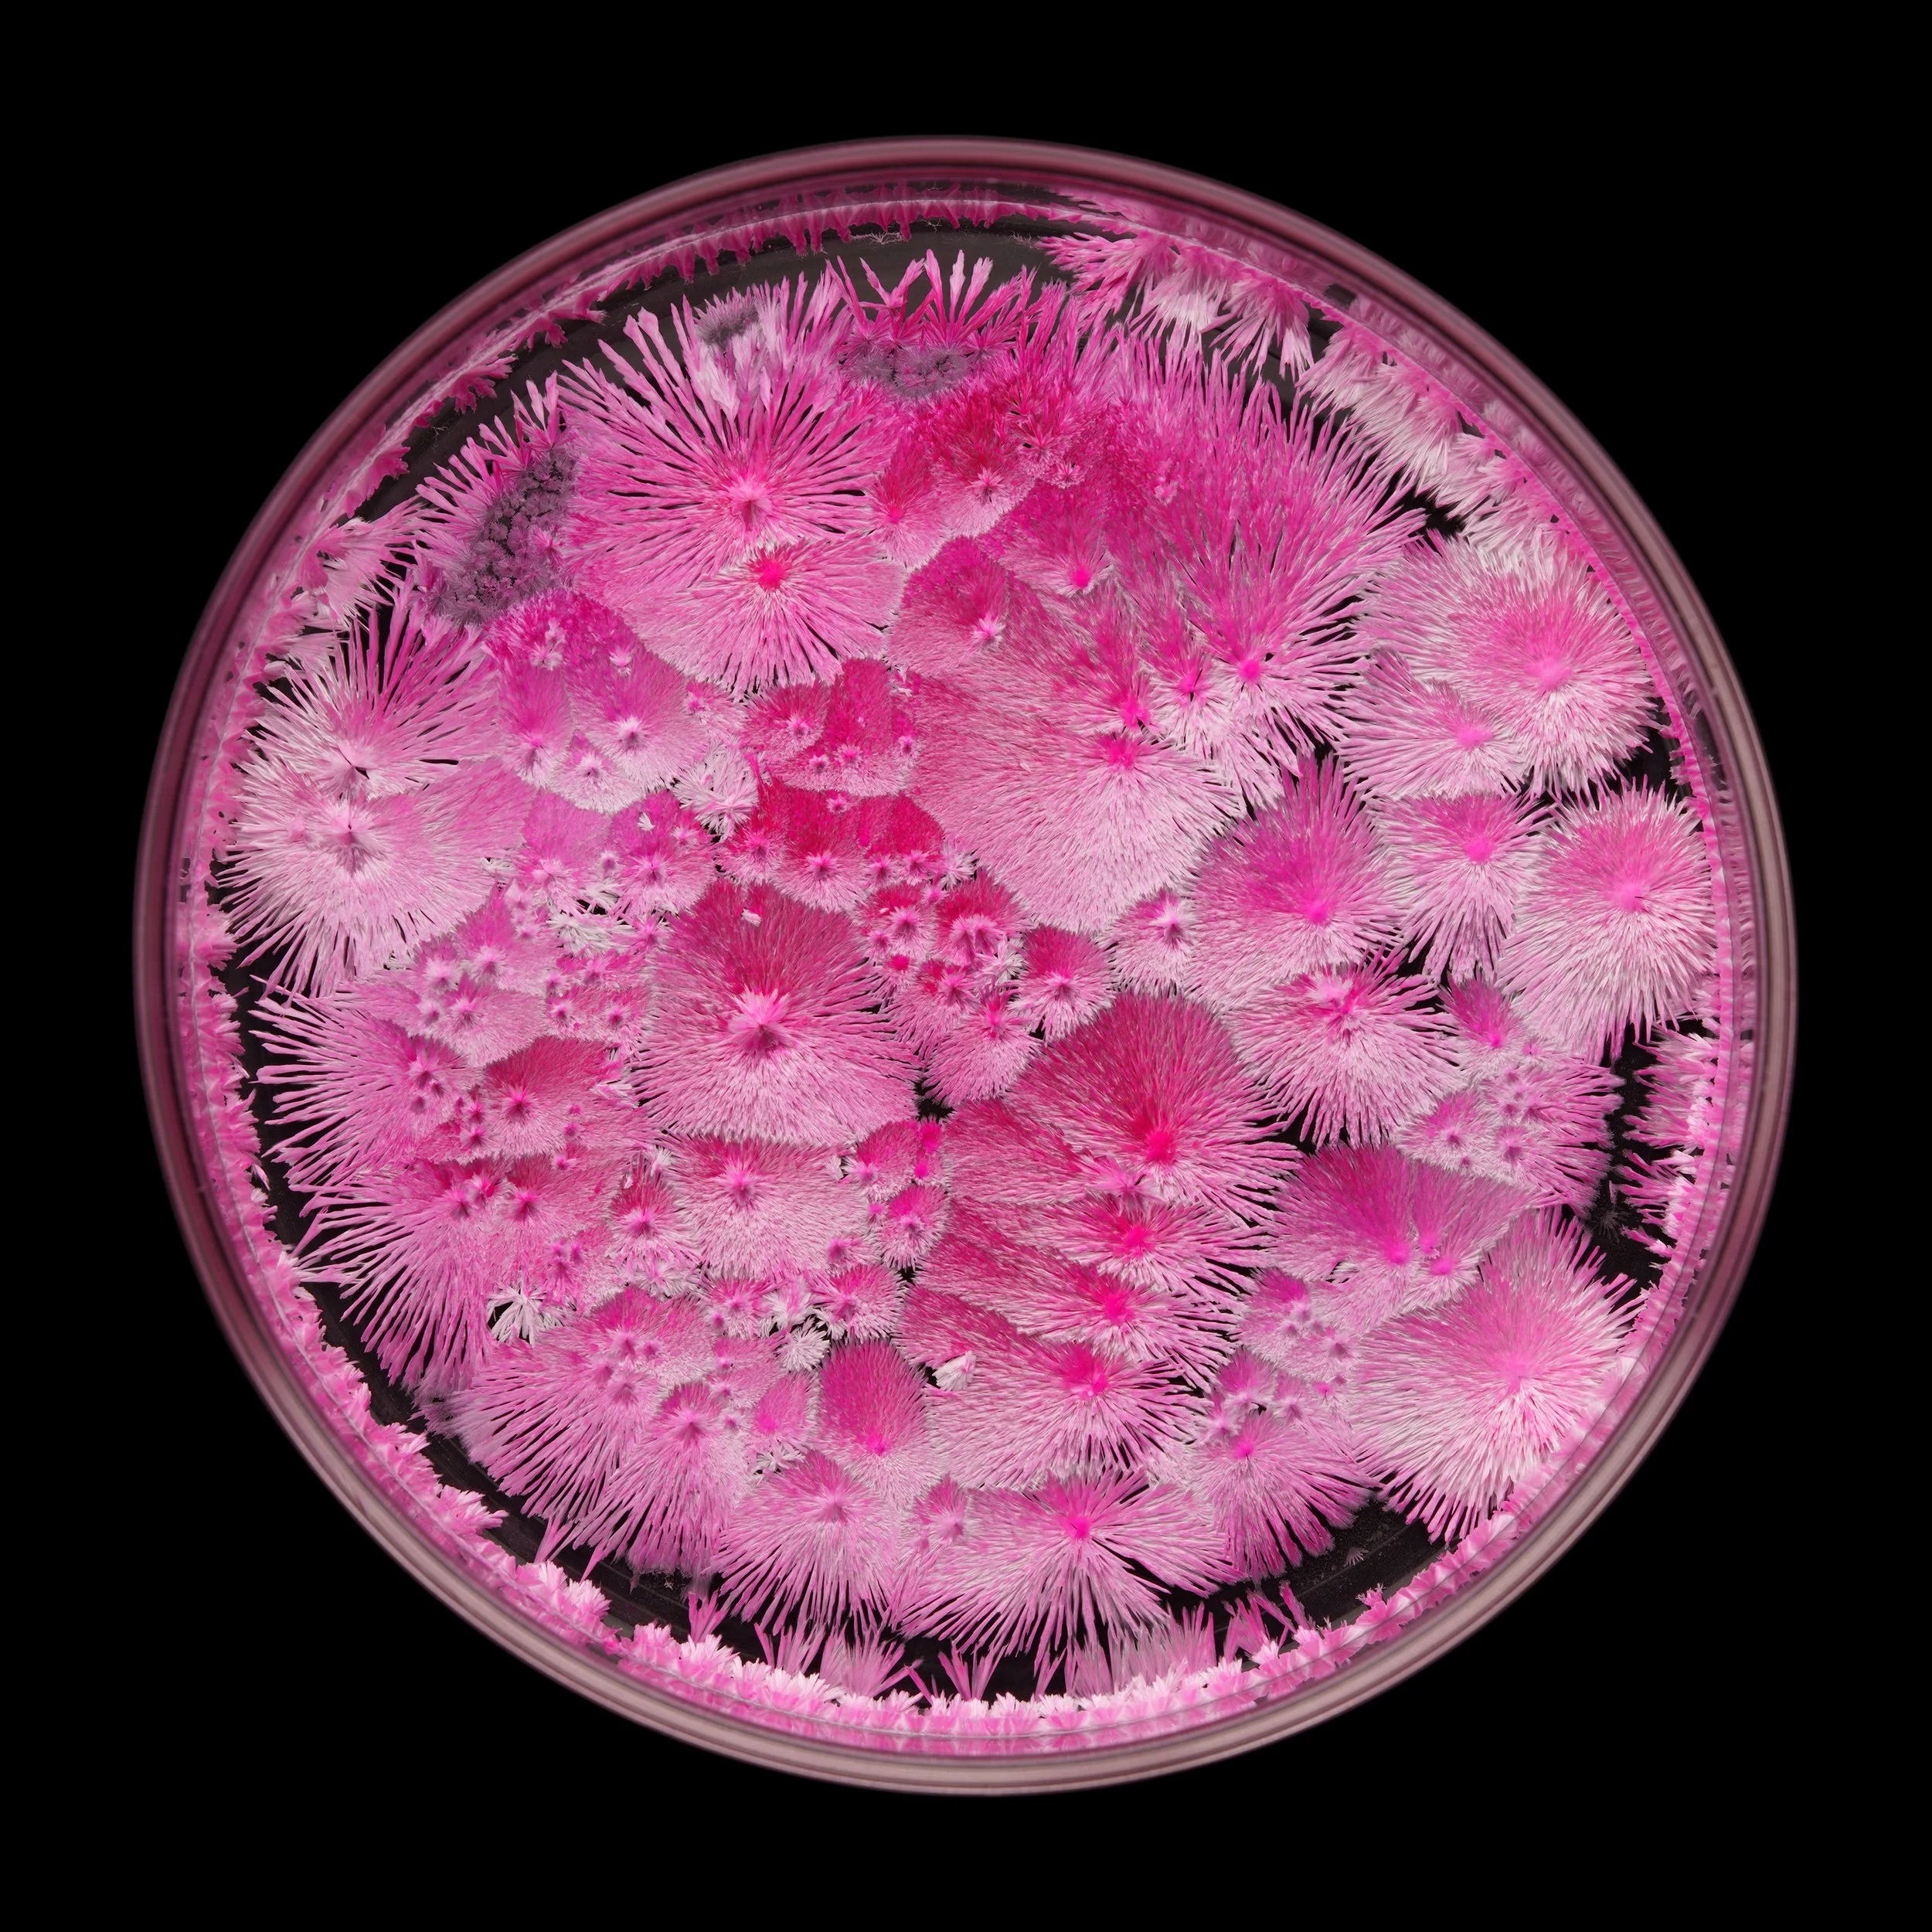
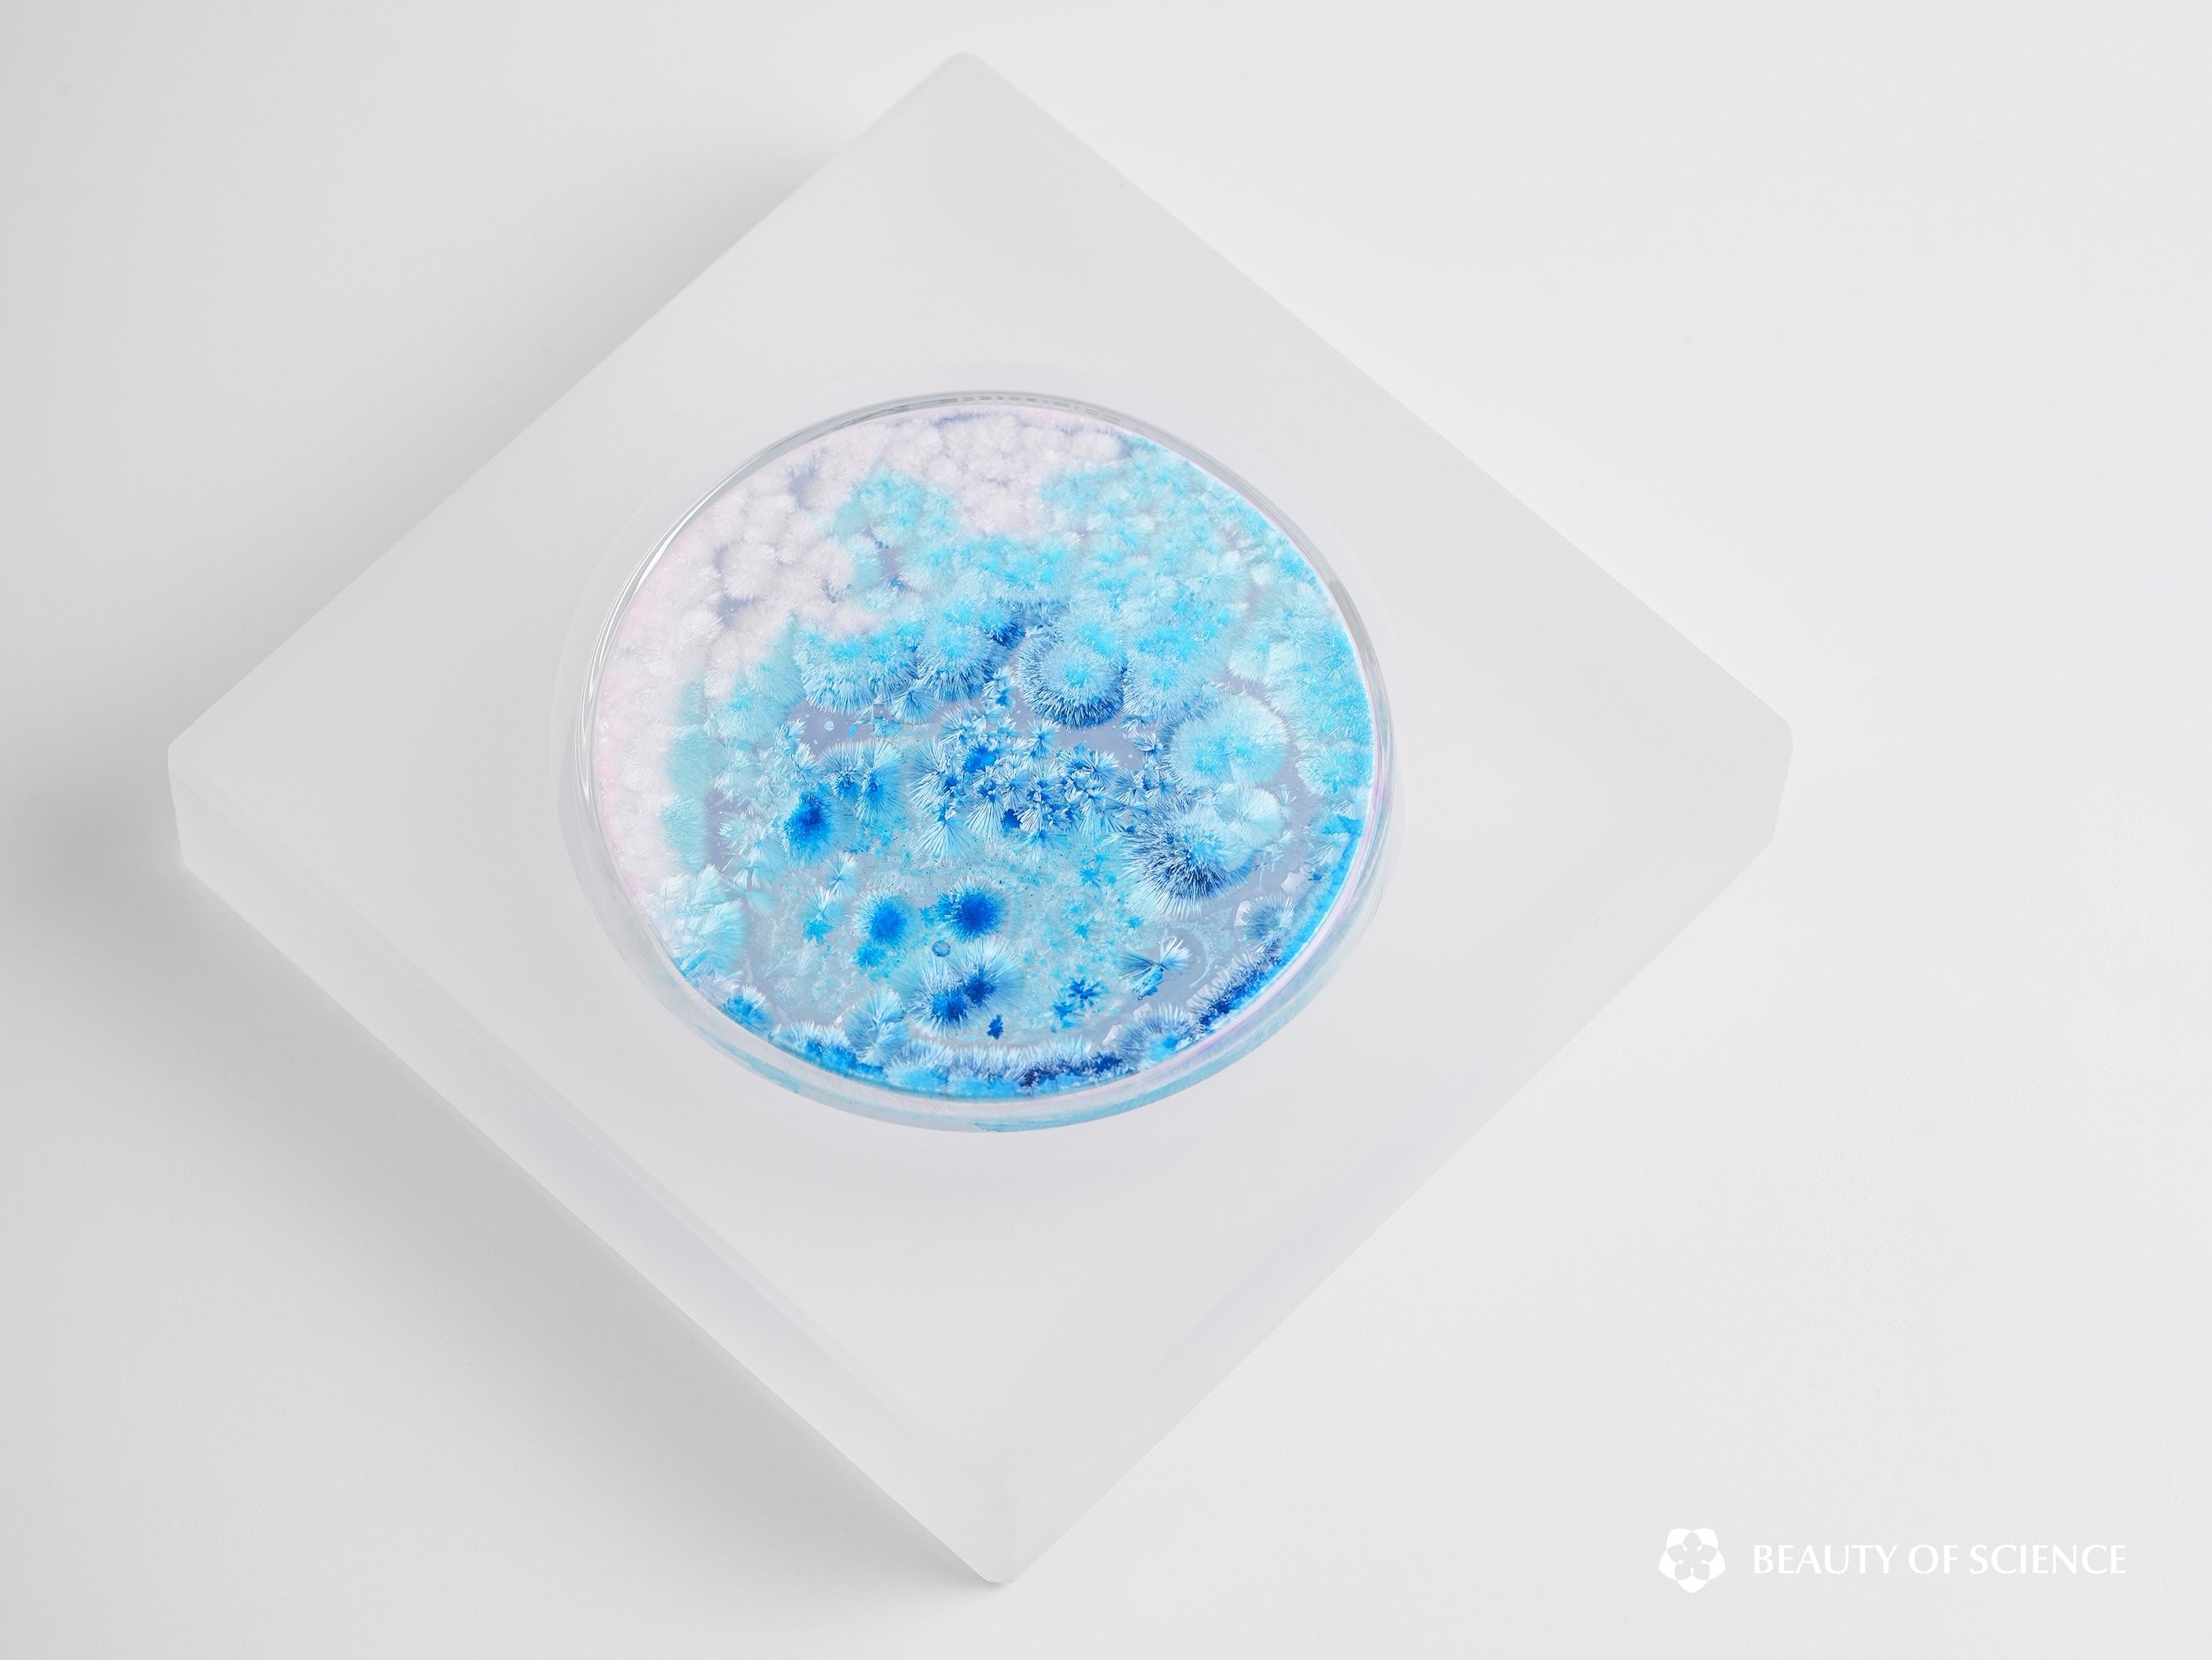

Crystal Garden
SEASONS
Crystal Garden: Seasons is an artist–nature co-authored crystallization art series. Guided by the principles of crystal growth, the work sets boundaries and conditions while allowing crystals to develop freely within them. By distilling seasonal imagery into an artistic language, it suspends nature’s ever-renewing transformations in petri dishes—crystals layering like branches and leaves, blooming like clustered flowers. Dense crystalline formations conjure seasonal landscapes.
Here, “garden” serves as a metaphor for the meeting of the natural and the man-made. A garden is a space where nature and human intention intertwine: neither wholly wild nor entirely artificial. We prune, arrange, and shape in an attempt to impose order, yet growth itself—and the turning of the seasons—reminds us that beauty in nature is never fully controllable. Crystal Garden: Seasons reveals the same delicate balance: crystal growth is guided by the artist’s parameters, yet it also unfolds through spontaneous evolution, where natural order and chance coexist. In this way, the work becomes a rhythm written jointly by creator and nature.
Through the vitality of crystalline forms and color, the series conveys nature’s sense of order and cadence, stirring a direct, intuitive resonance with the viewer. It also expresses reverence and praise for the natural world, offering an Eastern philosophical and poetic sensibility of harmonious coexistence between humanity and nature.
Petri-dish Gardens
Encased Works
Crystal Garden Micro-Landscapes
EXHIBITIONS
The Unveiled Palette SCI-ART Exhibition, Art Museum of Guangming Culture and Art Center, Shenzhen, China
The Unveiled Palette SCI-ART Exhibition, Art Museum of Guangming Culture and Art Center, Shenzhen, China
The Unveiled Palette SCI-ART Exhibition, Art Museum of Guangming Culture and Art Center, Shenzhen, China
The Unveiled Palette SCI-ART Exhibition, Art Museum of Guangming Culture and Art Center, Shenzhen, China
The 3rd China (Hefei) International Science And Arts Week, Hefei, Anhui, China
The 3rd China (Hefei) International Science And Arts Week, Hefei, Anhui, China